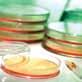

Este año la empresa productora de lácteos abrirá una nueva planta de producción, que promete ser una de las más modernas del mundo y continuará con el lanzamiento de nuevos productos. En entrevista con IAlimentos, Julián Jaramillo Presidente de Alpina, explicó, el porqué el pilar de crecimiento permanente de la compañía es la innovación.

pág.22
pág.20
Chile dispone de 21 tratados comerciales que podrían servir de plataforma de crecimiento de países como Colombia. Entérese de cuáles podrían ser sus oportunidades.

El mercado de los lácteos avanza. Economía, nutrición y salud, son las tendencias que liderarán el mercado este 2010.


pág.30
Editorial Pág. 6

Perfil Pág. 64
Novedades Pág. 66
Las 10 tendencias del consumo mundial: Independencia, comodidad y salud serán los aspectos preferidos por el consumidor este 2010 según Mintel.
PricewaterhouseCoopers, optimistas de precauciones: El 2010 será un año de ganancias para Colombia, pese a las consecuencias de la crisis, el país registrará un interesante crecimiento.


pág.10
pág.44

Detalles técnicos, mucho más que inocuidad alimentaria: El mantenimiento de la maquinaria influye de forma significativa en la calidad de los productos. Existe un enemigo silencioso de la inocuidad, entérese de cuál es.


La industria de alimentos tiene a su alcance un mundo de posibilidades en ingredientes con los que puede fabricar productos gourmet de calidad. Conozca cuáles son esas opciones.
pág.48
Gerente Canal Industria de Alimentos
ALEJANDRO QuINTERO OSORIO
cel: 318 772 8413 aquintero@revistaialimentos.com
Coordinadora Editorial IAlimentos
Ejecutivos de cuenta
CAROLINA BARBOSA HERNÁNDEZ
cel: 313 259 7093 cbarbosa@revistaialimentos.com
MARIBEL CORONADO RIVERA
cel: 316 650 3209 mcoronado@revistaialimentos.com
NADINE MORENO ANZOLA
cel: 317 359 0441 nmoreno@revistaialimentos.com
Colaboradores
DIANA CAROLINA SÁNCHEZ
cel: 316 704 7624 dianacaro13@yahoo.com
MILENA CLAVIJO
tel: 315 321 0081 mileclavijo@gmail.com
Jefe de diseño
Diseño y diagramación
Fotografía
YAMILE ROBAYO VILLANuEVA diagramador@revistalabarra.com
JORGE ANDRÉS CALDERÓN C. jcalderon@revistalabarra.com
CARLOS ANDRÉS ACERO R. cacero@axioma-group.com

JuAN FELIPE ALMONACID
cel: 310 569 8410 jualmona@gmail.com
NICOLÁS CABRERA
cel: 320 235 7997 nicolascabrera@gmail.com
www.axioma-group.com
Gerencia General
Consejo Asesor
Gerente de Contenido
Gerente Comercial
Editor General
Gerente de Eventos
MARCELINO ARANGO L. cel: 313 8157505 gerencia@revistalabarra.com
RICARDO ÁVILA CRISTINA VALDES
MARIANO ARANGO L. cel: 313 815 7510 director@revistalabarra.com
STEPHAN RAM[IREZ cel: 315 342 80155 gerentecomercial@axioma-group.com
GABRIEL PINEDA ARTEAGA cel: 314 218 4997 editor@axioma-group.com
JAVIER BENíTEZ GONZALEZ cel: 315 667 53 18 eventos@axioma-group.com
Gerente Financiera y Administrativa
Gerente de Talento Humano
Datos y Suscripciones
Gerente e-bussiness
Área web
Impresión
MERY ELLEN LARA melara@revistalabarra.com
PAOLA TEZNA asadmon@revistalabarra.com
DuBAN PASCAGAZA BENITEZ gerenciath@axioma-group.com
LILIANA CALDERÓN suscripciones@revistalabarra.com
ANDRÉS GÓMEZ agomez@revistalabarra.com
JONNATHAN DAZA jdaza@revistalabarra.com
PANAMERICANA FORMAS E IMPRESOS
uNA PuBLICACIÓN DE AXIOMA COMuNICACIONES LTDA. Tel: 236 6310 / Cra. 13 # 77A - 65 www.revistaialimentos.com.co
Marzo de 2010 / Edición Número 14 Bogotá, Colombia
HECHO EN COLOMBIA, POR COLOMBIANOS Prohibida la reproducción total o parcial del contenido de esta revista sin autorización expresa de los editores.
Preocupada por el futuro del café, la cadena cafetera ha enfilado sus esfuerzos hacia el crecimiento del consumo interno, con la campaña “Toma Café”. Es decir, llegó la hora de fomentar el consumo nacional, de venderle más café al consumidor colombiano. En otras palabras, en necesario incrementar las ventas y los productores han decidido que la alternativa es invitar a los colombianos para que consuman más.
El primer problema que se advierte con la estrategia es el planteamiento de la misma, puesto que ésta no pretende darle al consumidor lo que está buscando, sino ofrecerle algo que – tal vez – no haya solicitado. De ahí que el riesgo sea grande; y prometer un crecimiento del 30% en seis años no resultará tan fácil como parece. El segundo problema es el tipo de producto al cual se le está apuntando: el objetivo es lograr que se consuma un mayor número de tazas de café, o una mayor concentración de café en el mismo número de tazas que hoy se consumen. Lo cual no deja de tener un tono impositivo.
¿Realmente el colombiano quiere tomar más tazas de café? ¿Realmente desea un café más concentrado?
Pero esto no quiere decir que la estrategia esté condenada el fracaso. De
hecho no podemos establecerlo hasta que no sepamos si el colombiano está o no dispuesto a ello. Por lo tanto, es necesario preguntarnos cuál es la verdadera expectativa del colombiano con respecto a su producto emblemático. ¿Qué busca? ¿Dónde lo busca? ¿Cómo lo busca? Y ¿Cuándo lo busca? ¿Está la respuesta en una taza de café o en productos derivados?
Sin embargo, me atrevo a decir que la batalla no será fácil, pues cargamos una historia – de siglos atrás – que ha descuidado al consumidor nacional, dejándolo elegir cualquier calidad y preparación del café. Dejándolo elegir, de hecho, otros tipos de bebidas. De ahí que hoy la industria esté hablando de “educar al consumidor”; en otras palabras, de asumir una tarea que tenía olvidada desde hace muchos años.
Tal vez, generar conciencia sobre los beneficios del café; y ahogar los mitos que se han construido en torno a él genere algún tipo de crecimiento en el consumo. Por consiguiente, es valioso, válido y necesario desmitificar los riesgos de la salud del café; pero de manera responsable, con estudios y experiencias científicas. No obstante, no está claro si dicho esfuerzo sea suficiente para alcanzar la meta del 30%.


Considero que IAlimentos es seguramente una de las tres mejores publicaciones de América Latina.
Gracias y saludos.
Silveira Aparecido Marketing Director Danisco BrasilMe parece una revista con muy buena información, que nos puede colaborar en el mejoramiento de nuestra empresa.

Gracias y muchos y éxitos.
Por: Hernando José Gomez Restrepo Presidente del Consejo Privado de Competitividad
Aldemar
Rivadeneira Lopera Gerente Productos Fresgurth E.U.Palmira - Valle
Solomillo de cerdo

IAlimentos se permite corregir una información publicada en la edición No. 13 que actualmente se distribuye. Aclaramos que la imagen incluida en el artículo Cárnicos salud es la tendencia de la página 48, en la parte superior izquierda, no pertenece al archivo fotográfico de Friogán como se afirmó en el crédito publicado. La imagen del solomillo de cerdo, fue sumistrada por el Fondo Nacional de la Porcicultura. Pedimos excusas a todos nuestros lectores y a la Asociación Colombiana de Porcicultores.
En el segundo semestre de 2006, se creó el Sistema Nacional de Competitividad de Colombia con el objetivo de establecer un marco institucional encargado de la definición, el seguimiento y la coordinación de políticas públicas diseñadas para mejorar la productividad y la competitividad del país. El máximo órgano asesor del Sistema es la Comisión Nacional de Competitividad, del cual hacen parte el sector público, las empresas, la academia, las organizaciones laborales y las regiones, y la articulación está a cargo de la Secretaría Técnica Mixta, integrada por el Departamento Nacional de Planeación, el Ministerio de Comercio, Industria y Turismo, y el Consejo Privado de Competitividad.
En sus inicios, la Comisión Nacional de Competitividad estableció una Visión de largo plazo para Colombia en la que se proyecta, a 2032, un país con un ingreso por habitante cercano a los 20.000 dólares, similar a lo que hoy en día tienen países como Portugal o Corea del Sur, un índice de pobreza menor a 15%, una tasa de informalidad inferior a 40%, y una menor divergencia social y económica entre los departamentos y regiones del país. Esta Visión enmarca, en mi opinión, el deseo que tenemos todos para el futuro de Colombia.
Ahora bien, ¿cómo podemos alcanzar estos objetivos? En primer lugar, es
fundamental que el gobierno siga avanzando, con compromiso, en los temas críticos para la competitividad del país, especialmente en infraestructura y logística, formalización laboral y empresarial, ciencia, tecnología e innovación, y educación con pertinencia. En segundo lugar, se requiere impulsar activamente esas grandes reformas estructurales que el país tanto necesita en materia tributaria, laboral, financiera y de justicia.
Colombia se encuentra actualmente en un punto crítico de su historia. Podemos continuar con un desarrollo económico lento y dejar que otros países nos superen, o podemos consolidar los grandes avances de los últimos años y convertirnos en un modelo a replicar en la región. Para continuar por el mejor camino, es de gran importancia que el nuevo gobierno que se posesiona el próximo 7 de agosto muestre un fuerte compromiso y gran liderazgo con la política de competitividad. No podemos retroceder de los grandes avances alcanzados con la creación y la consolidación del Sistema Nacional de Competitividad. Necesitamos que la política de competitividad se convierta en una Política de Estado, en la cual participen activamente al sector privado, el sector público, la academia y las regiones. De lograr esto, el país podrá finalmente dar ese gran salto y alcanzar altos estándares de prosperidad colectiva.
2008 (primer semestre)
2009 (primer semestre)
Aguas embotelladas
Hogares colombianos que compran aguas embotelladas

79 % 82 %
Consumo promedio 25 lt. - 26 lt.

Desembolso promedio (COP$) $13.327 - $13.243
Número de visitas al punto de venta 8 - 7
Bebidas lácteas
Hogares colombianos que compran bebidas lácteas
79 % 82 %
Consumo promedio 6,7 lt. - 6,7 lt.

Desembolso promedio por kilogramo $32.382 - $31.327
Número de visitas al punto de venta 11 - 11
Aguas embotelladas

Grandes cadenas
Bebidas lácteas
En entrevista con IAlimentos, Lutz Goyer, Director de la Cámara de Proveedores y Canales de Distribución de la ANDI aseguró, que el 2010 será un año de retos para las grandes superficies. Nuevos jugadores entraran a competir en el mercado nacional y ante el bajo desempeño de las cadenas de supermercados, las promociones no serán una buena estrategia para aumentar el consumo.
IAlimentos: ¿Cuáles son los jugadores que ingresaran en el mercado nacional este 2010?
Lutz Goyer: Afortunadamente Colombia se ha vuelto atractiva para diferentes inversionistas y dentro de esos hay grandes cadenas que tienen entre sus planes llegar al mercado nacional, tal es el caso de Chile que se ha interesado por Colombia y ha llegado con Falabella, también llegó Easy en una alianza con el grupo casino francés y estamos a la perspectiva de que llegue también Riplay. Por otro lado, llegó a Colombia un coloso que pondrá en el país aproximadamente 100 tiendas, es la empresa Oxxo que en México tiene 7.600 puntos aproximadamente y una facturación de US$4.6 billones al año.
Siempre ha estado a la expectativa la llegada de Wal-mart a Colombia y aún no sabemos cuándo llegará, pero lo que sí ha hecho esa compañía estadounidense, es que ha venido a seleccionar proveedores para exportar de Colombia a Estados Unidos, lo cual ha sido una excelente oportunidad para algunos afiliados de nuestra cámara y lo cual hemos visto con muy buenos ojos.
Lutz Goyer Director Cámara de Proveedores y Canales de Distribución ANDIIA: ¿Qué significa la entrada de Atacadao en Colombia, cómo se percibe dicho competidor?
Lutz Goyer: Atacadao es solo un formato diferente de Carrefour con el que ya se ha experimentado en Brasil y ha resultado muy interesante. Se presume que tal y como se ha desempeñado en el país vecino, también podría funcionar en Colombia. La apertura del primer almacén está prevista para los primeros días de marzo y es un formato parecido al de Makro; es un mayorista que va a operar sin tarjeta de membresía y que tiene como objetivo ser una alternativa para que las tiendas
su desempeño es más alto que hace una década.
El año 2009 no fue bueno, el consumo decayó y la crisis financiera también se notó en Colombia aunque menos que en otros países; el consumidor se volvió más racional. El 2010 no tiene una tónica muy diferente, los primeros 6 meses del año serán un poco complicados porque lo que más afecta al consumo es el desempleo y sabemos que en Colombia el número de desocupados es muy alto y aún no se ve su punto de inflexión. El consumidor seguirá siendo prudente y las grandes cadenas van a tratar de atraerlo al punto de venta

compren allá sus insumos sin tener que ir a Corabastos, a plazas de mercado o sin tener que esperar a que llegue el proveedor. Para todo hay cabida y nosotros también estamos muy a la expectativa de cómo va a funcionar este nuevo formato.
IA: ¿Cuáles fueron los resultados del 2009 y qué se espera para este año?
Lutz Goyer: Las ganadoras del 2009 fueron las tiendas que han aumentado su participación y registraron un crecimiento muy favorable en los últimos años, hoy
con diversas estrategias, pero si los empresarios siguen pensando que hay que conquistar al consumidor únicamente a través de ofertas y promociones, pensamos que eso es una estrategia equivocada, hay que innovar con productos y hacer crecer categorías, no atraer al comprador a través de precios bajos porque el precio bajo se vuelve paisaje y deteriora el valor de las marcas.
IA: ¿Cuál ha sido la razón principal del bajo desempeño de las grandes cadenas?
Los primeros 6 meses del año serán un poco complicados porque lo que más afecta al consumo es el desempleo que en Colombia es muy alto.Fotografía: Nicolás Cabrera
En 2009 se vio una proliferación tal de promociones que se llegaron a sumar casi 330 durante el transcurso del año y eso ya es muchísimo más que en el año anterior. El 2009 lo podemos meter en la historia como el año de las promociones pero no del crecimiento, ahí ya tenemos la disyuntiva: más promoción = más crecimiento, no necesariamente, si la promoción solamente va a precio puede destruir valor.

Lutz Goyer: El tendero ha aprendido a ser empresario lo cual ha sido una excelente que ha hecho Fenalco. Por otro lado, el minorista se vuelve un elemento social importante dentro del sector en el que vive: fía, conoce a sus clientes y se vuelve parte de la comunidad. Mientras haya desempleo tendrá mayor preferencia la tienda de barrio y el tendero que satisface inteligentemente y con el surtido cada vez más amplio al consumidor. Nuestra recomendación para las empresas de alimentos este 2010 es: no descuide el canal tradicional, apoye y ayude al tendero.
IA: ¿Será el cambio de formato una buena alternativa de atraer a los compradores sin dañar el mercado?
Lutz Goyer: Empresas como Nestlé o Kellogg's hoy en día están vendiendo sus productos en formatos mucho más pequeños, efectivamente es mucho más inteligente hacer un empaque e innovaciones que vayan directamente al canal tradicional y a las tiendas para conseguir aumento de venta, que hacer promociones y bajar los precios, esto es lo que llamamos inteligencia de mercado.
IA: ¿Cuáles serán las oportunidades de las empresas nacionales en el exterior?
Lutz Goyer: Hay muchos proveedores y afiliados a la cámara que son empresas transnacionales, tenemos continuamente noticias sobre Alpina que está buscando poner un pie en Estados Unidos, Nacional
de Chocolates es una empresa muy activa con grandes exportaciones a países del área, Quala es una compañía que tiene planta en Venezuela, República Dominicana y México. Hay muy buenos ejemplos de empresas multinacionales y en el sector de alimentos que sin ser cadenas grandes, han dado el salto.
Éxito ha tenido una participación un poco dolorosa en Venezuela últimamente, pero podría dar el salto a otras naciones, y ahí tenemos el ejemplo de Olímpica que compró una participación de una cadena en Costa Rica e incursionó en Centroamérica. La internacionalización es importante y las empresas colombianas están muy preparadas para dar ese salto y compensar lo que el mercado local no les puede dar, a través de exportaciones, siempre será una alternativa sopesar el menor crecimiento de un país en otro que sea nuevo en el mapa geográfico de la empresa.
Cifras clave del sector:
• La industria de bebidas colombiana está por encima del 20% de la producción frente a EEUU.
• 4.1% creció la producción del sector en 2009 con respecto a 2008 según el DANE.

• 10 billones de pesos (2008) es el valor en el que hoy se traduce el fortalecimiento del sector lo que representa cerca del 2% del PIB nacional.
Seguir creciendo sobre la base de innovación en productos, es el interés principal de la Cámara de Bebidas de la ANDI. Aníbal Fernández de Soto, Director, manifestó en dialogo con IAlimentos que la industria de bebidas quiere visibilizarse como líder en transformación productiva, debido a que el sector sabe tomar las medidas para enfrentar la crisis y mantener índices de crecimiento importantes.
IAlimentos: Acabamos de pasar por uno de los periodos más difíciles a nivel económico ¿Qué tiene planeado el sector de las bebidas en Colombia para iniciar la recuperación?
Aníbal Fernández de Soto: Desde 2008 se vienen desarrollando con intensidad diversas y avanzadas estrategias
Datos históricos
Hace apenas una década, los indicadores de competitividad del Ministerio de Desarrollo Económico daban cuenta de caídas del 12.9% en la producción en el sector de bebidas, un descenso en ventas del 13.5% y tasas decrecientes en empleo por cerca de 5.6%.
comerciales por parte de las empresas. Durante el año 2009 el sector fue líder en innovación industrial debido, en buena parte, a la entrada de competidores internacionales que dinamizan todos los segmentos. La industria de bebidas en nuestro país también sabe cómo enfrentar
momentos de adversidad económica. El sector de gaseosas, por ejemplo, sufrió una desaceleración frente al ritmo de crecimiento que llevaba en años pasados. Sin embargo, en varias empresas han podido sortear las dificultades y finalizaron 2008 con incrementos en el volumen de ventas de 5%, en buena medida por la atención que han centrado recientemente en nuevas bebidas como el té y aguas embotelladas, los que han representado dos de los negocios que más han crecido en los últimos años.
IA: Es después de la crisis cuando se evidencian las necesidades y las falencias de los diversos sectores de la economía. ¿Cuál fue la debilidad más notable del sector y cuál la fortaleza con la que cuenta ahora?
Aníbal Fernández de Soto: Observando específicamente a la industria colombiana, son muy pocos los subsectores cuya productividad laboral les permitirá competir una vez entren en vigor los diferentes TLCs. Cabe destacar el caso del subsector de las bebidas, cuya productividad alcanza estándares de clase mundial y supera ampliamente la productividad laboral promedio (producto por empleado por año en dólares) de los Estados Unidos.
Desde el punto de vista del consumidor, el grueso del tema es variedad de productos y diversidad de tamaños, que en eso el mercado aún puede profundizar más, en la crisis la gente cambió muchos de sus hábitos de compra o bien para grandes o pequeños formatos,
porque en la gama media no había mucha opción. Lo cierto es que culturalmente el colombiano toma gaseosa y cerveza y eso no lo cambia ninguna crisis. Las amenazas de la industria de bebidas, son las mismas de cualquier sector: inestabilidad institucional y jurídica en el país.
IA: ¿Cuál fue en 2008 y 2009 el desempeño del sector de bebidas en el PIB nacional y cuáles son las expectativas para el 2010?
Aníbal Fernández de Soto: Según los resultados de la Muestra Mensual Manufacturera, las ventas del sector bebidas se mantuvieron relativamente estancadas en el 2009 frente al 2008. Para este año las empresas prevén un mejor comportamiento. El sector de bebidas representa cerca del 2% del PIB nacional.
IA: ¿En cuánto asciende la producción de bebidas en el país?
Aníbal Fernández de Soto: Estamos hablando de cerca de 10 billones de pesos, es decir, cerca del 10% de PIB nacional. En Colombia las empresas de bebidas que conforman la Cámara son empresas que recogen el 80% del sector, estas empresas son muy grandes y por ende tienen un peso económico significativo, desde el punto de vista de empleos, de impuestos y la presencia regional que tienen, incluso desde el punto de vista histórico cultural. La nueva Cámara nace con ocho afiliados: Bavaria, SAB Miller, Coca Cola Servicios de Colombia, Coca Cola Femsa, Postobón, Nestlé, Red Bull de Colombia y Pepsicola Panamericana.
Los Productos lácteos son sinónimo de alimento completo y el compañero ideal en cualquier momento del día. Con base en nuestra experiencia algunos de los factores a tener en cuenta en la correcta selección de un sabor para este tipo de productos son los siguientes:
Contenido de grasa: Especialmente en el caso de los yogures es importante, ya que los materiales involucrados dentro de la formulación del saborizante difieren en su solubilidad (coeficiente de reparto); que resulta en una percepción distinta en productos con alto contenido graso a diferencia de aquellos de bajo contenido graso.
Edulcorantes artificiales: La sacarosa es el principal edulcorante en los productos lácteos. En los niveles normales de uso 8-14%, ésta tendrá una tendencia a resaltar el sabor dando una sensación de palatabilidad muy agradable en la boca. En los productos de dieta donde se utilizan edulcorantes artificiales como el Aspartame y el Acesulfame K; que tienden a dejar su distintivo residual metálico, una cuidadosa selección del sabor debe ser llevada a cabo junto con la evaluación sensorial sobre el producto terminado, para garantizar que dichas notas serán enmascaradas.
Presencia de almidones modificados: En algunos casos, cuando se utilizan este tipo de materiales en los productos lácteos, se pueden presentar reacciones entre los grupos carbonilos de los componentes del saborizante
y la estructura helicoidal de los materiales hidrocoloides, sitios dentro de la cadena pueden ser ocupados por estos grupos generando cambios en perfil del sabor.
Proceso térmico: En el caso de las bebidas que se someten a procesos de pasteurización o ultrapasteurización, se generan pérdidas de materiales volátiles componentes del saborizante que desbalancean el perfil original. Dependiendo de la volatilidad del sabor, una mayor dosis debería ser usada o el saborista podría realizar un cambio por materiales más estables térmicamente.
Acidez: El nivel de acidez en bebidas lácteas con sabores frutales, por el mismo carácter de la base no permite que ácidos normalmente usados en las bebidas a base de agua, se puedan utilizar. La falta de acidez hace que ciertas notas se opaquen o por el contrario se destaquen otras generando un pobre balance en perfil. Una reconstitución de la formulación se hace necesaria para caracterizar el sabor en el producto final.
Disaromas S.A. interpreta las necesidades de sus clientes y del mercado ofreciendo soluciones en saborizaciones emergentes de pitaya, papaya, ciruela, arazá y granadilla entre otras sin olvidar las exitosas saborizaciones tradicionales. Permítanos apoyarlos en el desarrollo de su proyecto a través de trabajo conjunto con nuestros saboristas expertos, en tiempo real y con la agilidad que el mercado exige.


Resultados que iluminan el camino
Encuesta Anual Global de CEOs

¿Cuál es la expectativa de crecimiento que tiene de su negocio en los próximos 12 meses?
América Latina
Porcentaje de crecimiento esperado por región.
El consenso logrado este año durante la sesión de clausura del Foro Económico Mundial llevado a cabo en la ciudad de Davos, Suiza, gira entorno a que el mundo está mejor que hace doce meses. La recuperación aunque es frágil, seguirá siendo el común denominador entre las naciones, sin embargo, serán diferentes los ritmos de crecimiento y las cifras dependerán de la estrategia y la posición adoptada por cada país.
Las opiniones de los empresarios más influyentes del mundo son heterogéneas, algunas positivas y otras un tanto ambiguas, sin embargo, Diego Henao, Socio de Consultoría de PricewaterhouseCoopers planteó para IAlimentos una visión optimista, que indica mejores resultados en la época de postcrisis para las empresas que se desempeñan en Colombia.

IAlimentos: ¿Cuál es el panorama del 2010 para los empresarios de Colombia frente al mundo?
Diego Henao: Es positivo y hay signos alentadores que
indican que el 2010 va a ser mucho mejor que el 2009. Vemos una economía creciendo a niveles no muy altos, pero vemos dicha evolución como el despegue de cifras mejores probablemente para 2011 – 2012. Seguramente tendremos unos índices de crecimiento por el orden del 2% y el 3%, hay perspectivas halagüeñas, sin embargo existen algunos temas que preocupan de manera significativa.
A nivel regional, permanece la amenaza grande de Venezuela, pero en cambio hoy existen vínculos comerciales interesantes con otros países: esperamos que las relaciones con Ecuador continúen mejorando, que Centroamérica se consolide como una alternativa importante. Finalmente, siempre estará a la expectativa qué va a pasar con Estados Unidos, ahí es donde está nuestro gran mercado y nuestro gran potencial, sin embargo, el Tratado de Libre Comercio (TLC) sigue siendo una gran incógnita y creemos que en el corto plazo no vamos a tener TLC, por lo tanto los empresarios colombianos tienen que considerar las demás cartas que están puestas sobre la mesa, para jugar en el corto plazo.
IA: ¿Cuáles son los actuales riesgos de la industria de los alimentos?
Diego Henao: A nivel nacional veo dos indicadores muy importantes: en primer lugar el desempleo, pues los índices son muy altos y el segundo es el gasto público y el déficit fiscal, que han alcanzado niveles preocupantes en los últimos años. El sector de los alimentos no es muy afectado por los cambios económicos, en la medida en que es un sector que responde a necesidades primarias, pero lo que si preocupa, es que el consumidor no tenga capacidad de adquisición.
IA: ¿Este año veremos los efectos de la crisis en las empresas, cuáles serán las mejor libradas?
Diego Henao: En la época de la crisis hubo dos tipos de compañías: unas que pararon sus proyectos por la incertidumbre y otras que en cambio siguieron adelante porque tenían productos ganadores y una estrategia ganadora hacia el mercado. Aún con mucha preocupación, estos últimos verán que con la innovación de sus productos y la agresividad con la que plantearon el acceso a ciertos mercados, adquirieron ventaja competitiva y evidentemente es cuestión de saber que con un producto y una estrategia ganadora, puedes llegar a ser exitoso en una economía que apenas despega su crecimiento o que se está recuperando.
IA: ¿En cuanto a gestión empresarial cuáles son los principales retos de Colombia y qué medidas se deberán adoptar?
Diego Henao: Aquellos que tienen presencia en mercados internacionales deben estar preocupados con el tema del dólar, la divisa norteamericana no despega y de acuerdo con los analistas, no se espera avance en el corto plazo. A nivel interno el desempleo y la baja capacidad de consumo, representan una restricción importante para el crecimiento de industrias y a nivel de la economía como tal, los crecimientos planteados no son excelentes noticias, pero tampoco son malas y hay espacio para crecer.
Lo otro es ver un poco cuáles son las movidas que se vayan a dar a nivel internacional con los grandes jugadores del sector. Recientemente ha habido noticias de consolidación de la industria como lo que pasó con Cadbury y Kraft. No sorprendería que ese tipo de cosas se sigan dando y hay que analizar muy bien qué movimientos de ese estilo se van a dar a nivel internacional, y en qué forma podrían impactar la industria colombiana.

IA: A propósito de los resultados obtenidos por PricewaterhouseCoopers de la encuesta anual mundial de directores ejecutivos en el Foro Económico Mundial, ¿qué están pensando los gerentes de las compañías más importantes del mundo?
Diego Henao: El problema de la crisis y la recesión, trajeron grandes enseñanzas para los empresarios. Hoy existe gran preocupación ante los movimientos regulatorios a nivel mundial, las medidas que está tomando el presidente Obama por ejemplo, son muy orientadas a regular la actividad de los bancos y no solo de la banca comercial, también de la de inversión y en eso sí genera preocupaciones importantes. Así lo vimos recientemente con la introducción de nuevos impuestos a la cerveza en Colombia, el empresario siente una amenaza significativa y opta por parar los procesos de inversión y crecimiento.
“
” 2010 va a ser mucho mejor que el 2009, tendremos unos índices de crecimiento por el orden del 2% y el 3%.Maylin Shiu Cliente Development Analyst - Latinoamérica

Para mantener la competitividad se necesita algo más que la capacidad de reaccionar al mercado, es necesario anticiparse a él. Maylin Shiu y Kenneth Monarrez especialistas en inteligencia de mercado de Mintel, explicaron a IAlimentos cómo las empresas del sector deberán enfrentar el 2010 y cuáles son las tendencias más importantes del consumo en la actualidad.

IAlimentos: ¿Qué posición deberán asumir las empresas de alimentos en el 2010 con respecto al comprador?
Mintel: Muchos consumidores están cambiando su estilo de vida, por lo tanto las empresas deben actuar rápido e innovar en productos que satisfagan las necesidades de la actualidad. En el 2010 el precio y las estrategias de mercadeo serán de suma importancia, ya hemos visto; por ejemplo, que el 50% de los consumidores en Reino Unido compran más durante las promociones, sin embargo el 28%

está recortando la compra de productos considerados complacencias. Minoristas y empresas de productos han reaccionado ante esta tendencia bajando la porción del producto un 30% y el precio un 10%, pero esta estrategia solo funciona en productos considerados ¨treats¨ o placeres. Habrá que determinar cuál es la estrategia correcta para cada segmento del mercado.
entre otros. En el caso de Estados Unidos y Europa, los consumidores actuales prefieren cosechar sus propias verduras y frutas o comprar los ingredientes frescos o productos menos procesados para cocinar. Las compañías ya están reaccionando a dicha tendencia y un claro ejemplo de ello es Tesco (cadena multinacional de locales de venta al por menor), que ha retomado la venta de alimentos tradicionales.
2. Comodidad: Muchos consumidores tienen un estilo de vida agitada por el trabajo y están buscando productos de conveniencia o funcionalidad. En tiempos pasados preferían sentarse en un restaurante y recibir un servicio completo, hoy en día prefieren restaurantes tipo ¨fast dinning¨ o productos de rápida preparación.
3. Una vida más saludable: De acuerdo con las encuestas realizadas en Estados Unidos, el 90% de los consumidores trata de mantenerse más saludable y se está
IA: ¿Cuáles son las prioridades del consumidor actual?
Mintel:
1. Independencia: Los consumidores de hoy buscan mayor autonomía, están ampliando su educación a través del Internet, aprendiendo cómo cocinar, maquillarse, hablar una nueva lengua,
cuidando más que antes, pero la manera como se mantienen sanos es diferente a la de hace algunos años. En lugar de visitar a sus doctores en busca de consejos saludables, hoy evitan ir al doctor y muchos compran vitaminas, alimentos fortificados, y suplementos para mantener un sistema inmunológico más fuerte.
Si las empresas tienen un producto totalmente nuevo en el mercado, este es un buen año para introducirlo.Kenneth Monarrez Account Executive - Latinoamérica
IA: ¿Cuales son los cambios más notables que ha producido la crisis económica en la población?
Maylin Shiu: Después de un año en el cual los consumidores han enfrentado la recesión en sus vidas, en el 2010 se verán cambios sociales y de comportamiento tales como:
4 5 6 7 8 9 10
4. La resistencia: En 2010 los consumidores demuestran un deseo de recuperarse con un mejoramiento de las actitudes y determinación reforzada. Resistencia, abarcará un nuevo conjunto de habilidades como la "nueva economía", cocinar, preparar comidas, y hacer un presupuesto de los alimentos.
5. Reconsideración /Re-valuación: Los consumidores volverán a evaluar su situación actual, hemos visto un aumento de la importancia del concepto ¨valor¨ para la nueva economía, y todos han adoptado medidas de austeridad. El precio será un factor de suma importancia para el 2010.
6. Evasión: Mintel predice escapismo como una tendencia para este 2010, los consumidores buscaran maneras de huir de la tiranía del ¨value¨ o valor, recortando y ahorrando a través de compras grandes, el consumo nunca había sido exclusivamente racional... y nunca lo será.
7. Más y nuevos medios de comunicación: El último año se ha visto una mayor adopción de redes sociales y medios interactivos por parte de los consumidores. En el 2010 se verá mayor entrada de estas formas de comunicación en la vida cotidiana y mayor interés en que dichas herramientas simplifiquen los deberes y tareas diarias. Los consumidores estarán buscando lo que viene en la esfera de los medios de comunicación.
8. Compruébamelo – Responsabilidad: Debido a que los consumidores tuvieron menos confianza durante el 2009, en el 2010 exigirán pruebas y resultados. Esa exigencia, no es un tema nuevo, pero hoy en día con tanta información, tantas ideas compitiendo, ideologías y opciones, los consumidores tienden a perderse.
9. Responsabilidad ética: Aunque hemos presenciado el aumento de la responsabilidad social corporativa y esfuerzos de sustentabilidad en los últimos años, en el 2010 dichas acciones serán aún más importantes para que los consumidores salgan de la inactividad de gastos. La ética desempeñará un papel importante y será de mucha influencia durante las compras. Para que las empresas logren reconstruir sus marcas a través de esfuerzos éticos, tendrán que considerar la conexión que tienen con el consumidor y habrá que darle razones emocionales para que compre.
10. Estabilidad: Hemos dejado el exceso de gasto de las últimas décadas y es ahora cuando nos damos cuenta que la moderación y la preparación son posibilidades para tener estabilidad. Mintel predice que en el 2010 aumentará la búsqueda del equilibrio y el reajuste de la situación económica como lo estamos viendo ahora, adaptando nuevos estilos de vida.

“
” La transparencia solía ser un elemento diferenciador entre las empresas, ahora será un requisito.
Desde el 2004 el colombiano experimentó una migración en consumo de alimentos, pasó de la compra de ingredientes para cocinar, a comer por fuera de la casa y adquirir pre-cocidos, hubo una expansión importante de categorías. A finales del 2008, la situación se complicó con una inflación del 13% y al aumentar el precio de los alimentos, los hogares volvieron a la tradición de cocinar en casa y cargar con sus preparaciones. Camilo Herrera, Presidente de Raddar conversó con IAlimentos sobre la situación actual del consumidor colombiano y las razones por las cuales, habrá un inminente regreso del portacomidas.
IAlimentos: ¿Cuál será el comportamiento de la categoría de alimentos durante este año que comienza?

Camilo Herrera: Para el segundo semestre del 2010 habrá estabilidad en el precio de los alimentos, pero durante los primeros seis meses el efecto del niño va a causar un ruido muy grande. Veremos un crecimiento de la categoría de alimentos de aproximadamente el 1.3%, pero una inflación cercana al 6.9%. Por otra parte, los productos funcionales tendrán mucha más fuerza, los

insumos están entrando con impulso a cumplir normas de responsabilidad empresarial y eso va a cambiar el mapa del mercado de una manera significativa. El reto de los productores de alimentos estará en educar al consumidor en el uso correcto de los productos y lo que estos ofrecen, el discurso publicitario ya no funciona y lo hemos visto en góndola.
IA: Entonces, ¿Cuáles serán las estrategias que deberán adoptar las empresas para incrementar el consumo de los colombianos?
Camilo Herrera: Será necesario buscar nuevas formas de transmitirle el valor de los productos al consumidor. ¿Qué hace que yo consuma más de un producto que de otros?, que ese producto me ofrezca un valor agregado, pero el problema de los alimentos y de todas las categorías de consumo es que hay saturación. Y ¿cómo hago para que alguien consuma mas de mi producto?, tengo que estar más presente en su ciclo de vida, desde el desayuno hasta la cena, tengo que estar permanentemente en su bolsillo y en su imaginario para que cuando él tome la decisión de compra diga: “el precio no me afecta si recibo un gran valor de esa marca o de ese producto”. Coca cola ha logrado ser líder en ese aspecto, está en todos los momentos de consumo.
Estructura del consumidor según canasta IPC y Raddar consumo.Fotografía: Nicolás Cabrera Camilo Herrera Presidente de Raddar.
Cuidado con las promociones, el año pasado fue espantoso en el manejo de las ofertas, destruyeron marca y destruyeron precio. Este último, es un sistema de información y si el consumidor percibe un valor mucho más bajo en un producto que habitualmente cuesta más, se va a sentir estafado y pierde lealtad. Crear marca es la única forma de competir.

IA: ¿Cuáles han sido las categorías de mayor consumo?
Camilo Herrera: Las categorías de mayor consumo sin duda fueron el arroz, la carne y la papa, claro está que con sus respectivos sustitutos por región. El arroz siempre ha sido y seguirá siendo un alimento transversal e importante, tanto que Harinera del Valle y Pastas La Muñeca se lanzó con un producto bastante agresivo que es la pasta con forma de arroz.
¿Qué prima en Colombia?, las gaseosas con una fuerza impresionante y en este momento lo líquido ha tomado mucho más fuerza, están todas las sopas y las cremas así como las importaciones de productos como los noddels. En la casa la comida tradicional sigue liderando el consumo, así como en las instituciones educativas se conserva el principio tradicional de la alimentación. Lo que liderará este año, son los productos alimenticios con tres valores fundamentales: funcionalidad, carga ecológica y productos muy sofisticados para la generación joven de cocineros.
IA: ¿Cuáles son los valores en los cuales estarán dispuestos a invertir los colombianos?
Camilo Herrera: En Colombia el 60% de la población por su problema de ingresos gasta en alimentos y solo el 10 o 15% de la población restante invierte y sabe que la compra es una decisión racional que debe tener unos condicionamientos nutricionales, de funcionalidad y otros tantos valores. Lo que viene este año, es un mantenimiento del consumo tradicional y el consumidor se convierte en prosumidor, compra cosas para cocinar y cada vez mas deja de comer en la calle, prefiere cargar con el portacomida. El ciudadano consume, el ciudadano produce, el ciudadano será un prosumidor.
IA: Conociendo la situación actual del consumidor ¿Cuál es el canal de compra preferido?
Camilo Herrera: La tienda de barrio es intocable, es la dueña y la señora del mercado, compra en grande para vender a granel, fía y además es la mejor herramienta de las marcas. Los canales tradicionales lideran el mercado por el fenómeno de la capacidad de compra.
IA: ¿A qué deberá apostarle la industria de los alimentos este año?
Camilo Herrera: Tiene que haber cambios, mercadeo y una vinculación en marca muy fuerte, hay marcas que sobrevivieron la crisis como hay otras que salieron quemadas y eso lo veremos con más claridad este año. El reto del 2010 es lograr aumentar el consumo en la categoría y estar más tiempo al día con cada persona. Por ejemplo, el arroz tiene un enemigo natural, y es la estética, el sobrepeso, pero se metió la pasta diciendo, “yo si puedo ser light”, va a ser un choque fuerte y el reto de los productos de alimentos es estar todo el día o más veces con el consumidor.
“
” Veremos un crecimiento de la categoría de alimentos de aproximadamente el 1.3%, pero una inflación cercana al 6.9%.

Chile cuenta con una de las cifras de Producto Interno Bruto (PIB) per cápita más altas de América Latina US$14.528, tiene 16,8 millones de habitantes y una tasa de crecimiento muy estable, promediando el 5%. Dentro del contexto comercial latinoamericano, el país está en un proceso de desarrollo económico ejemplar y representa importantes oportunidades para los empresarios de otras partes del mundo.
Según Proexport Colombia, las exportaciones no tradicionales de 2008 a Chile registraron US$326 millones y los principales productos exportados fueron: azúcares, mieles y plásticos en formas primarias. De acuerdo con el Departamento de Desarrollo Estratégico de ProChile, las exportaciones realizadas por Colombia hacia el país austral durante el año 2008, registraron un crecimiento del 6,8% en relación al año 2007.
Chile y Colombia han mantenido relaciones comerciales sólidas sustentadas en convenios como el Acuerdo de Complementación Económica desde 1994, en cuya vigencia se incluyen las cifras
anteriores. La participación de Colombia en el mercado Chileno, podrá ser mayor con el ahora vigente Tratado de Libre Comercio, que se firmó durante el Gobierno Bachelet desde mayo de 2009.
Alimentos, interesante campo de acción

Datos de ProChile señalan que la industria frutícola chilena se ha convertido en un escenario importante de exportación hacia otros países, con ventas por US$2.600 millones en el 2008. La oportunidad que existe en dicho sector está en que la nación suramericana debe aumentar a 500 mil, las hectáreas plantadas de fruta para lograr exportaciones de US$4 mil millones. En cuanto a la pesca y productos acuícolas, el país busca atraer inversión en mejoras tecnológicas para el desarrollo de nuevos productos de consumo humano, que no atenten contra el medio ambiente. La pesca en Chile representa el 40% de los envíos de alimentos y el 2% del PIB nacional.
Por otro lado, el clima, las condiciones fitosanitarias y el suelo, así como los altos estándares agroindustriales, representan

La reducción y eliminación de barreras no arancelarias, licencias e impuestos a la importación, han convertido al país suramericano en un escenario realmente promisorio.
una ventaja significativa de competencia para Chile cuando de producción de aceite de oliva se trata. Sin embargo, se espera aumentar las inversiones en olivos para que el país gane participación en el mercado de las grasas vegetales, en la actualidad el aceite de oliva representa solo el 2,5%.


En el sector cárnico, Chile ha venido creciendo a una tasa anual del 5% en la última década y se requiere incrementar la producción para atender las demandas de carne ovina de países como China, Corea, y Japón.
Plataforma hacia otros mercados
Chile cuenta con 21 acuerdos comerciales en vigencia con aproximadamente 56 países, tales negociaciones representan un acceso preferencial a un mercado de más de 4.000 millones de personas; 90% del PIB mundial. El país Suramericano es en la actualidad una plataforma para terceras naciones que pueden aprovechar la red del TLC a través de los llamados encadenamientos productivos.
Los destinos de exportaciones chilenas han ido cambiando, Asia ha tomado un papel preponderante y existe potencial de exportación a otros mercados para países como Colombia debido a que la rebaja en acceso para Chile es en promedio del 88%.
Realizando encadenamientos productivos a través de dos modalidades: Alianzas entre empresas colombianas y chilenas o instalación de la empresa colombiana en Chile, es posible acceder a rebajas arancelarias, el proceso incluye tres etapas:
1. El material o partes ingresa de Colombia a Chile con arancel 0% (TLC).
2. Se realiza el proceso productivo en Chile para cumplir con la regla de origen y poder acogerse al beneficio arancelario en el mercado destino.
3. Exportación del bien final (que cumple origen chileno) a los países de interés.

Alpina cerrará el 2010 con una nueva planta de producción en Entrerríos Antioquia, y como complemento a sus exportaciones de producto al mercado latino en Estados Unidos completará ventas por 30.000 dólares durante este año a través de internet.

Para hablar de Alpina acertadamente es necesario mencionar la palabra innovación. Es evidente, que la multinacional productora de alimentos, fundada en Colombia hace 64 años, ha logrado un admirable posicionamiento debido a la decisión de fortalecer las dinámicas de investigación y desarrollo año a año.
En el tercer trimestre de 2009 la compañía registró un crecimiento en ventas netas del 5% frente al tercer trimestre del año anterior, con un monto ascendente a $282,702 millones. Más del 30% del valor logrado en ventas proviene de productos desarrollados en los últimos 3 años. Es claro que para la compañía, el lanzamiento constante y efectivo de nuevos productos, es la clave del liderazgo y además permite una mayor visibilidad de las necesidades del consumidor, mientras se fortalece la manera de atender el mercado y se evoluciona en los procesos internos.
Julián Jaramillo presidente de Alpina explicó a IAlimentos cuáles son las expectativas de la organización para este 2010, y porqué la razón principal para que la empresa se haya convertido en líder de diversas categorías, ha sido y será siempre la innovación.
IAlimentos: Este 2010 será para los especialistas en finanzas y economía un año de crecimiento lento pero prometedor ¿Cómo percibe Alpina el año que comienza?
Julián Jaramillo: Vemos el 2010 con optimismo y seguimos con el reto de mantener el crecimiento de nuestra Organización. Continuaremos trabajando por generar bienestar en toda nuestra cadena de valor y en todos los lugares donde estamos presentes. Le apuntamos a crecer de la mano con nuestro entorno de manera sostenible. Vale la pena mencionar que este año traerá hechos muy relevantes para Alpina como es la inauguración de nuestra planta en Entrerríos, Antioquia. Esta será una de las plantas más modernas del mundo en la producción de yogurt y contribuirá con la descentralización de nuestra operación. Además, traerá beneficios para las comunidades lecheras de Antioquia y desarrollo para la región.
“
Este año traerá hechos muy relevantes para Alpina como es la inauguración de nuestra planta en Entrerríos, Antioquia.

Será la segunda planta más importante de Alpina en Colombia y la más moderna de América Latina en la fabricación de yogures y bebidas lácteas. “Creemos firmemente en generar prosperidad a esa región de Antioquia. Ésta es una región agroindustrial, lechera, donde esperamos crear 300 empleos en las primeras fases de la operación, además de los empleos que ya venimos generando durante la construcción”.
En Colombia, se ve aún una producción y consumo de bebidas de muy bajo contenido de fruta, que no es la mejor opción en términos de salud y bienestar para los consumidores. Por esta razón Alpina trae una propuesta de jugos y néctares muy saludables:

Frutto

Frutto Vitalis



Fruper con Nutrimix Soka


IA: ¿Cómo fue el desempeño de la compañía en términos generales durante el 2009?
Julián Jaramillo: Aún bajo una coyuntura de desaceleración económica mundial, Alpina logró defender la rentabilidad del negocio y presentamos crecimientos en nuestras ventas. El enfoque en innovación y los lanzamientos de nuevos productos, permitieron presentar comportamientos favorables durante el 2009. En términos de rentabilidad, los resultados reflejan las acciones de productividad derivadas de las inversiones de capital en las líneas de producción y tecnología, así como las iniciativas de control de gastos implementadas por la Corporación desde principios del 2009. A su vez, la emisión de bonos que realizamos en el mes de febrero de 2009 permitió mejorar el perfil de los vencimientos de deuda. A pesar de haber tenido un año complejo, logramos crecer y fortalecer nuestra organización para así prepararla de cara a las coyunturas económicas favorables que con seguridad vendrán en los próximos años.
IA:¿Qué representa para Alpina la innovación?
Julián Jaramillo: La innovación hace parte del ADN de Alpina. Para nosotros la innovación e incorporación de conocimiento científico y tecnológico a nuestros productos y procesos es un objetivo con el que trabajamos diariamente. Contamos con una red de cooperación científica con los principales
centros de desarrollo de alimentos en el mundo que se canaliza a través del Instituto Alpina, cuya misión es impulsar el conocimiento en el sector de la alimentación y crear productos de valor agregado. En el 2008, la Compañía lanzó 48 productos nuevos. Más del 30% de las ventas de Alpina provienen de productos desarrollados en los últimos 3 años. En 2009 desarrollamos cerca de 80 proyectos al año y existe plena capacidad de sacar al mercado 40 proyectos a nivel corporativo. La tasa de éxito de lanzamiento de estos productos es del 70%. Esto significa, que la Organización (Colombia, Venezuela, Ecuador y Estados Unidos), puede lanzar un producto nuevo cada 1.2 semanas.
IA: ¿Cuál ha sido la estrategia de Alpina para lograr que los productos funcionales tengan éxito y posicionamiento?
Julián Jaramillo: Para posicionar nuestro portafolio de productos, en primera medida, tenemos un respaldo científico fuerte. Contamos con redes de conocimiento y de cooperación científica con los principales centros de desarrollo de alimentos del mundo. Tenemos el Instituto Alpina, que cuenta con un Consejo Científico conformado por un grupo de especialistas en diversas temáticas relacionadas con la salud y la nutrición humanas, que aportan conocimiento científico para fortalecer las plataformas de la alimentación funcional y definir las futuras líneas de investigación de la Compañía. Los productos
Más del 30% del valor logrado en ventas proviene de productos desarrollados en los últimos 3 años.”Fotografía: Nicolás Cabrera
Con la reducción de tiempo para cumplir con todas las actividades, han cambiado los hábitos alimenticios, se han ido deteriorando las funciones gastrointestinales de la población y la salud de los consumidores se ha visto afectada.
Es por esto que se ha incrementado la demanda de productos alimenticios que además de aportar valor nutricional, ayudan a mantener el estado de salud del organismo. Hoy en día los fabricantes de productos alimenticos han implementado el uso de cultivos probióticos palabra que traduce: “Por la vida”.
Para que un organismo sea definido como probiótico debe reunir algunas características como ser habitante normal del intestino humano, no ser patógeno, producir sustancias antimicrobianas y tener capacidad para aumentar de modo positivo las funciones inmunes y las actividades metabólicas. Y la fibra prebiótica genera los siguientes beneficios: mejora la estabilidad y el funcionamiento intestinal, reduce los desordenes
intestinales, mejora la protección contra la infección intestinal y el cáncer de colon, fortalece el sistema inmunológico, se alivia la intolerancia a la lactosa, mejora la digestión y la absorción de nutrientes, reduce el colesterol en la sangre.
Estas bondades las podemos encontrar en alimentos como néctares, jugos, bebidas lácteas, chocolatinas, arequipes, gomas, productos en polvo y gelatinas; en los cuales Cimpa Ltda ha mantenido una importante participación.


Cimpa Ltda. es el soporte y el aliado en el desarrollo e innovación de productos funcionales de alta calidad con aporte tecnológico y gran compromiso con la competitividad de las industrias procesadoras de alimentos. Es por esto que ofrecemos un portafolio único: cultivos lácticos probióticos, fibra dietaria prebiótica, estabilizantes y emulsificantes, sistemas funcionales cuajos, bioconservantes, sabores, edulcorantes, productos para la higiene y desinfección en planta y un acompañamiento a sus desarrollos y procesos.

funcionales de Alpina son avalados por distintas sociedades científicas. Por ejemplo, la Asociación Colombiana de Gastroenterología (Regeneris) y la Asociación Colombiana de Alergia, Asma e Inmunología (Yox). Adicionalmente, una de las tareas más importantes, es la labor en manos del equipo de Mercadeo de la Organización, de crear la comunicación con la que se da a conocer el beneficio del producto.


Con una inversión de cerca de 100.000 dólares en la página Web y con las activaciones que buscan llevar tráfico a la página en EEUU y en Colombia, se espera que por este canal se completen ventas por 30.000 dólares durante este año, como complemento a sus exportaciones de producto al mercado latino en Estados Unidos. A través de la página web, que utiliza el portal de e-commerce de Amazon.com se comercializarán: avena, arequipe, compotas y yogurt con cereales, al igual que anchetas con productos.
IA: ¿Cuáles son los destinos de exportación y las proyecciones internacionales de la compañía, cúal ha sido el desempeño de las plantas ubicadas en Ecuador y Venezuela aún cuando permanecen inestables las relaciones con esos países?
Julián Jaramillo: Hoy día tenemos plantas de producción en tres países: Colombia, Ecuador y Venezuela y exportamos nuestros productos a Estados Unidos, que es en este momento nuestro principal mercado a nivel de exportación y a Perú, Bolivia y Aruba, Curaçao entre otros países del Caribe. La exitosa penetración en estos mercados se basa en un trabajo disciplinado de innovación, así como en la diversificación.
Estados Unidos representa un mercado muy importante en materia de exportación. En el 2009 nos enfocamos en fortalecer el mercado de los consumidores hispanos residentes en ese país y para ello desarrollamos distintas actividades como el lanzamiento de la página www. alpinaus.com, mediante la cual se quiere fortalecer la venta de nuestros productos como arequipe y avenas. En Venezuela tenemos producción local y estamos allí desde 1993. Hoy en día participamos con cuatro categorías de producto: bebidas lácteas (Avena), yogures (Yogurt Líquido, Yogurt Firme, Bonyurt, y Regeneris), refrescos (Frutto) y postres (Petit Alpina). Con respecto a Ecuador, donde también tenemos operación local, culminamos con éxito en el 2009 la fusión de Alpina con la empresa ecuatoriana Kiosko-Proloceki, empresa líder en el mercado de quesos de este país. Hoy día contamos allí con una planta en la ciudad de Machachi y otra en la ciudad de San Gabriel. En Perú, hemos tenido igualmente éxito con la exportación de avenas, compotas endulzadas con fructuosa y quesos maduros.

IA: ¿Cuáles han sido las más recientes inversiones de la compañía?
Julián Jaramillo: Aparte de la planta de Entrerríos en Antioquia, otra de las inversiones que hemos trabajado desde el 2008 es el nuevo edificio administrativo en Sopó. En Alpina concebimos nuestras nuevas instalaciones pensando en el bienestar de nuestros empleados. Es por esto que el diseño del edificio administrativo de Sopó, que se encuentra en construcción, se realizó bajo los lineamientos del USGBC (United States Green Building Council), que a través de la certificación LEED (Leadership in Energy and Environmental Design), promueve el uso eficiente y sostenible de agua y energía,
“
”
Hoy día tenemos plantas de producción en tres países: Colombia, Ecuador y Venezuela y exportamos nuestros productos a Estados Unidos.
el uso de materiales locales y reciclados y materiales con bajos niveles de emisión de COV (compuestos orgánicos volátiles), usualmente presentes en pegantes, pinturas, plásticos. Igualmente, renovamos la flota de transporte de Alpina, con camiones más modernos y eficientes e invertimos en la actualización de la plataforma tecnológica de la Organización que inició a principios de 2010 y esperamos culminar a principios del próximo año.

IA: El desempleo es una de las preocupaciones más notables e importantes de los colombianos en este momento ¿Que podría decir Alpina sobre ese tema en particular, cuál ha sido la experiencia de la compañía al respecto?
Julián Jaramillo: Nuestros colaboradores y su desarrollo son el motor del crecimiento y sostenibilidad de Alpina y por ello trabajamos en un plan de cultura y clima organizacional que pone en marcha nuestra estrategia de atracción y mantenimiento del talento en la Organización, al igual que la capacitación y fortalecimiento de jóvenes para formarlos como futuros líderes. Parte de este objetivo es la protección del empleo. Durante el 2009 por ejemplo, y debido a la desaceleración de la economía, trabajamos en un programa de control de gastos en todos los niveles y áreas de la organización, con el fin de defender el empleo y el bienestar de nuestros colaboradores.
Es nuestra meta cercana ofrecerle al consumidor estadounidense, productos Alpina diseñados para sus necesidades y expectativas. Estamos convencidos de que las características de los productos Alpina pueden ganar la preferencia de los consumidores de los Estados Unidos y estamos trabajando para lograrlo.
IA: ¿Cuáles han sido los principales cambios de tendencia en mercados de consumo masivo que ha registrado Alpina?
Julián Jaramillo: Existe una conciencia cada vez más fuerte hacia el cuidado de la salud a través de la alimentación, del ejercicio y de productos que ayuden a beneficiar alguna función del cuerpo, sea el sistema cardiovascular, las defensas, la digestión, el desarrollo mental, la piel, los huesos, entre otros. Vemos que la principal motivación del consumidor colombiano para la elección de sus alimentos sigue siendo los factores nutricionales. Esto demuestra que en la actualidad, ha crecido el interés por lograr una alimentación “saludable”. A éstos le siguen otras como el hábito, el prevenir enfermedades, entre otros. Otra tendencia es hacia el rescate de lo natural. El sector de alimentos ha evolucionado en el desarrollo de mejores empaques amigables con el ambiente, comunicación en doble vía con el
Alpinito Miti-Miti Regeneris Fibra Plus Regeneris bebible y cuchareable - Venezuela
Línea Postres de La Cabaña

Queso Manchego Alpina Provolone
ampliación del mercado con la entrada de nuevos jugadores.
IA: ¿Cuál fue la experiencia de Alpina con la optimización de recursos financieros y qué consejos podrían seguir los empresarios?
consumidor así como una mejora de la capacidad logística de respuesta oportuna y acciones decididas en responsabilidad social empresarial.

IA: ¿Cómo ha percibido Alpina la presencia de un competidor internacional prometedor como lo es Danone?
Julián Jaramillo: La entrada de nuevos jugadores significa una mayor dinamización del mercado. Creemos que
Julián Jaramillo: En el 2009 nos enfocamos no solamente en el crecimiento de las ventas sino en la defensa y crecimiento de nuestra rentabilidad. Los resultados obtenidos reflejan las iniciativas de control de gastos implementadas por la administración en todas las áreas de la compañía desde principios del 2009. Este programa de control de gastos permitió mejorar nuestros márgenes operacionales durante un año 2009 de coyuntura de mercado difícil, y en combinación con una optimización de capital de trabajo, concretamente en inventarios, logramos mejorar nuestra posición financiera
La operación y los logros de la compañía tienen su base en un comprometido equipo humano de más de cinco mil personas, con un clima laboral armonioso y un ambiente propicio al crecimiento personal y colectivo. Ellos constituyen la columna vertebral de Alpina.
Quinta empresa con mejor reputación corporativa en Colombia del Monitor Empresarial Español de Reputación Corporativa- MERCO-.
Primer lugar en la encuesta Élite Empresarial del diario Portafolio, como la empresa con productos de más alta calidad de un total de 1100 empresas.
Business Alliance for Secure Commerce (BASC), en su Premio al Líder en la formación de Cadenas Seguras, destacó a Alpina por sus buenos sistemas de seguridad y control en su cadena logística.
para los consumidores es más atractivo tener múltiples opciones a la hora de elegir y escoger la opción que mejor se acomode a sus necesidades. En Alpina confiamos en la calidad, naturalidad y valor agregado de nuestros productos que son el resultado de importantes procesos de innovación. Podemos decir que nuestro liderazgo se afianzó en el proceso de
y generar recursos internos para la culminación de inversiones que Alpina había iniciado años atrás. Más que un consejo es contarles la oportunidad que vimos en Alpina de que aún en situaciones de desaceleración coyuntural de mercado, existen varias formas para mejorar la posición competitiva y financiera de las empresas.
Mejor queso del año en Mercoláctea de Argentina, Premió al queso Brie.
Premio al mejor libro del mundo sobre quesos en el Gourmand Cookbook Awards - París con el libro Expertos Queseros.

En el 2009 nos enfocamos no solamente en el crecimiento de las ventas sino en la defensa y crecimiento de nuestra rentabilidad.Talento humano
Somos una empresa 100% colombiana con más de 12 años de experiencia en la obtención y suministro de proteínas animales para diferentes industrias, donde la sangre bovina (con su alto contenido proteico y funcional), se convierte en la materia prima fundamental de nuestra empresa, la cual es recolectada, transportada, transformada, almacenada y distribuida bajo estándares de calidad e inocuidad, garantizados por nuestra certificación BPM-HACCP.
Nuestro sistema de recolección higiénica de la sangre, que aplicamos en diferentes plantas de sacrificio a nivel nacional, genera grandes beneficios. Somos consientes de que trabajamos con uno de los subproductos de mayor cuidado ambiental, que por su volumen, su estado liquido y su alto componente proteico es sumamente exigente.
Frigodan es un excelente aliado en la reducción de impactos ambientales negativos propiciados por la sangre. Nuestro proceso incluye el transporte de la sangre para ser procesada en nuestras dos plantas ubicadas en Bogotá y Medellín, desde donde se abastece todo el territorio nacional. Nuestra oferta de valor va dirigida a industrias de alimentación humana, nutrición animal y farmacéutica, soportada en una asesoría y acompañamiento permanente en las aplicaciones, confiabilidad en el suministro y un proceso continuo de investigación y desarrollo.
Nuestros productos

En la línea de alimentación humana contamos con proteínas líquidas y congeladas con diferentes concentraciones, proteína desecada y hemoglobina líquida o en polvo, con presentaciones de acuerdo a la necesidad de nuestros clientes y del mercado.

Estas proteínas poseen características funcionales y nutricionales de gran interés para la industria alimentaria, tales como:
- Son de origen animal aportando el requerimiento de aminoácidos esenciales.
- Tienen un poder de retención de agua de hasta 1 a 9 en la presentación en polvo.
- Poseen una alta capacidad de gelificación, que se da desde los 38ºC y que puede soportar temperaturas de esterilización generando un gel no reversible.

- Capacidad emulsificante en relaciones hasta 1:6:6
- Aporte de hierro hemico, que por su origen tiene un gran valor nutricional por su alta biodisponibilidad en la dieta.
Estas características hacen de nuestros productos una alternativa de gran valor para la industria de alimentos, donde se aprovechen las propiedades de las proteínas.
Excedentes por baja demanda, alta informalidad y un acopio concentrado en pocas industrias son algunas de las problemáticas que el sector lácteo enfrenta en la actualidad.
uno de los sectores más golpeados de la industria de alimentos por la caída de las exportaciones a Venezuela es el lácteo, que ya venía confrontando el deterioro del consumo interno de leche y la caída en los precios internacionales de este alimento. Pero no es ese el único frente en el que se vislumbran oportunidades de mejora, pues los actores de este sector también están enfrentando la competencia de importaciones incrementales de dos productos: los lactosueros, que se utilizan para “rendir” la leche, desmejorando la calidad del producto en términos nutricionales, y la leche en polvo subsidiada en sus países de origen, que pone a los productores colombianos en desventaja en su propio mercado.
La problemática del sector es bastante compleja y aunque para muchos consumidores la cara del producto es la industria pasteurizadora, son los ganaderos quienes llevan la responsabilidad de la producción a unos costos cada vez más altos por coyunturas tales como el Fenómeno del Niño y el cambio climático.

Tradicionalmente, los pequeños, medianos y grandes productores de leche, desde los que tienen dos cabezas de ganado hasta quienes poseen cientos, son quienes se encargan del pastoreo, alimentación y extracción del preciado alimento, para después venderlo a los centros de acopio de la industria láctea, la cual se encarga de los procesos de pasteurización, producción de los derivados y comercialización.
Según cifras de Fedegan, de los 6.520 millones de litros producidos en 2008, un 43% (2.827 millones de lts) se destinaron a los canales informales, mientras un 47% se van a la industria, representada por el líder Colanta (12%), los demás productores (32%) y algunas pequeñas cooperativas (3%). Se puede concluir entonces que cerca de la mitad de la leche producida se distribuye a través del sector informal, aquel

que la vende por cantinas o litros puerta a puerta, sin ningún tipo de procesamiento y que puede tener graves consecuencias para la salud de quienes la consumen si el tratamiento ha sido indebido.
Esto se agrava si se tiene en cuenta que más del 80% de los colombianos se encuentra en estratos del 1 al 3, y para ahorrar dinero prefieren comprar la leche a través de canales informales. Frente a ese particular, José Félix Lafaurie, Presidente de Fedegan, afirmó que la informalidad “es un atentado contra la salud pública, supone competencia desleal porque impide la entrada de nuevos jugadores y frena la dinámica de los existentes, además de ser un freno para las exportaciones y un facilitador de las importaciones”.
Dentro del sector, productores e industria se encuentran en extremos opuestos, cada uno tratando de obtener el mejor precio para sí. Este año, los ganaderos vieron reducirse sus expectativas sobre este tema, pues el Ministerio de Agricultura dictaminó este año que el incremento del precio que la industria les debe pagar a los productores por litro de leche es de solo el 1.48%. Ellos esperaban al menos el 2.7% y una prima de verano por seis meses, ya que las sequías encarecen aun más los costos de
Fuente: DANE - Cálculos: Oficina de Planeación - Fedegán
producción de leche y durante 2009 no hubo incrementos de los precios al productor. Por eso, Fedegan ha prendido las alarmas sobre el riesgo de que con tan pequeño incremento en el precio, la producción de leche colapse en el lapso de 4-6 meses.






Para Lafaurie, existen grandes deficiencias en la comercialización de los productos lácteos y además, los productos que fabrican las pasteurizadoras están dirigidos a clientes de estratos altos, todo lo cual es un caldo de cultivo que hace prosperar a la informalidad.
En la misma línea, el mercado nacional ha venido experimentando una baja importante en la demanda en las categorías de leche pasteurizada y leche en polvo y no se han realizado campañas para fortalecerla y atacar todos los paradigmas que sobre el producto se tienen, así como resaltar sus beneficios nutricionales y por ende, para la salud.
“Se han generado muchos mitos acerca de la leche y falta un concepto claro de sus beneficios. Es un producto que tiene mucho trabajo incluido y a la gente le sigue pareciendo que tiene un costo muy alto, comparándolo con las gaseosas, los jugos o el agua”, estima Hernán Uribe, Gerente General de ANALAC.
Según datos de esta misma entidad, el consumo per cápita de leche en Colombia es de 130 litros y la cifra proyectada al cierre de 2009 es ligeramente inferior, observándose una caída en 2006, que si bien ha sido contrarrestada, sigue mostrando una clara tendencia a la baja. Estas cifras contrastan con las de la Unión Europea, donde el consumo per cápita ronda los 170 litros. Al respecto, Lafaurie comentó que “Si se incrementara el consumo en 5 litros per cápita por año, desaparecerían los actuales excedentes equivalentes a 10
días de producción, que nos tienen hoy ‘enlechados’”.
Según Jorge Andrés Martínez, Director Ejecutivo de ASOLECHE, el mercado de la leche ha cambiado sustancialmente en los últimos años gracias a los diversos procesos de consolidación de la industria, lo cual ha permitido que se amplíen las compras de leche en el país para llevar productos lácteos de alta calidad a los consumidores. Este proceso se ha visto catalizado por la entrada de empresas multinacionales que han dinamizado la actividad de la industria láctea.
“En los últimos años han entrado compañías como DPA —un Joint Venture entre Nestlé y una compañía neozelandesa (cooperativa)—, Danone, —apoyando a La Alquería—, Gloria, —compañía peruana que compró a Algarra—, y la pasteurizadora Parmalat, que tras su entrada compró a Proleche. No obstante, el líder en volumen sigue siendo Colanta”, indica Uribe. Además de estas empresas, Martínez resalta a Alival, Alpina, Freskaleche, Lechesan, El Recreo,
“La informalidad es un atentado contra la salud pública, supone competencia desleal porque impide la entrada de nuevos jugadores y además frena las exportaciones”.
Santo Domingo, El Pomar, La Mejor, y La Pradera.
En cuanto al desarrollo de la leche como producto, “la tendencia de los alimentos funcionales tiene un crecimiento significativo en los productos lácteos, dirigidos hacia un consumidor cada vez más interesado en la salud y los beneficios aportados a ésta por los alimentos. Distintas bebidas lácteas con funciones específicas como la mejora de la función digestiva o la eliminación del colesterol, se posicionan como alternativas novedosas de nutrición y salud”, afirma Martínez.

Algunos desafíos.
Para José Félix Lafaurie, las exportaciones de leche en Colombia adolecían de una excesiva concentración, pues el 90% de las mismas, estaba dirigido a Venezuela. Al comenzar el “bloqueo” comercial, se apreciaba ya una caída libre en la cifras con respecto a 2006, año en que se dio un importante pico en la actividad exportadora de leche debido a los altos precios del producto. Esto implica que el sector necesita con urgencia una estrategia de penetración de nuevos mercados y para eso necesita calidad.
Por otra parte, se observa en las cifras de importaciones una tendencia incremental, que los productores atribuyen a leche producida con subsidios en sus países de origen y que pueden estar afectando negativamente al producto nacional en términos de precio, por lo cual han solicitado al Estado que se incremente el arancel al producto externo, particularmente en la categoría de lactosueros.
Frente al tema de la producción, Fedegan estima que “hay mucho productor y poca industrialización”, pues si bien ha habido un incremento en la oferta, el acopio formal o compra por parte de la industria disminuyó en 28 millones de litros al comparar el período enero-abril 2008 Vs 2009. Todo esto redunda en baja de los precios al productor, que además se ve afectado por la estacionalidad en la producción de leche, pues en los veranos se hace más difícil producir por la escasez de forraje y agua, en cambio, cuando hay invierno la producción mejora.



de la salud (OMS) resume el concepto de probióticos como los microorganismos vivos que al ser ingeridos o asimilados producen cambios positivos en algún aspecto de la salud. Para que un probiótico pueda ser suministrado vía alimentaria al ser humano tiene que cumplir algunas características: debe existir alguna compatibilidad entre el alimento y el microorganismo, es necesario asegurar la presencia de una cantidad idónea de un microorganismo particular en una porción de consumo y finalmente, ese microorganismo debe colonizar la parte del cuerpo humano que se espera afectar positivamente.
La actual industria láctea debe responder a las inquietudes de salud pública y tener en cuenta para sus innovaciones, elementos de la población como edad, sexo, el componente racial, la alimentación condicionada culturalmente y el estilo de vida de las comunidades. Para diferenciarse ante el consumidor, es necesario ofrecer opciones novedosas y lograrlo es posible cuando se invierte en microorganismos identificados, con efectos positivos validados clínicamente y aprobados por las autoridades sanitarias de los países que lideran la investigación de probióticos.

El estrés y la alimentación inapropiada han permitido una incidencia muy alta de trastornos en la salud. En la actualidad las necesidades del consumidor van desde las afecciones del sistema inmune hasta dolencias en el sistema gastrointestinal.
Los productos lácteos son el mejor vehículo de masificación de los probióticos debido a que se distribuyen a los puntos de venta en forma refrigerada, lo que garantiza la conservación de los microorganismos. Además, esta industria por tradición está familiarizada con la incorporación de microorganismos en sus procesos.
Para lograr una acción efectiva de los probióticos, los seres humanos deben ingerir en promedio, 4.000 millones de microorganismos al día.
Más de dos terceras partes del sistema inmune del organismo se encuentran en el intestino y los alimentos pueden ser la vía más efectiva de ataque hacia el sistema digestivo.

La flora bacteriana intestinal se conforma de millones de bacterias al interior del intestino grueso que producen sustancias beneficiosas para la salud.
Las bacterias que proliferan en el intestino, intervienen en el desarrollo del sistema inmunitario y en la regulación de la respuesta del organismo ante amenazas.
La flora intestinal participa en la digestión y producción de algunas vitaminas e incrementando la resistencia del organismo frente a los patógenos.
Investigaciones vigentes

• Urex® es un nuevo probiótico que se está desarrollando de forma exitosa. Se usa para mantener el equilibrio de la flora vaginal y se toma como pastilla en forma oral.
• Los probióticos podrían ser útiles en un futuro en disminución de enfermedades de base alérgica, prevención de infecciones urinarias, disminución de los niveles de colesterol, etc.
La oferta de microorganismos en Colombia incluye cepas específicas que aportan un importante valor agregado a los productos para consumo humano.
BB-12® Bifidobacterium bifidus: Es una cepa especialmente usada para regular el tránsito intestinal. En un ensayo realizado en el Hospital Universitario de Helsinki en Finlandia, las personas mayores que recibieron una dosis diaria de un billón de células de BB-12 experimentaron una mejora significativa en su peristaltismo, comparados con el resto del grupo.


LA-5® Lactobacillus acidophilus: Mejora la salud gastrointestinal y tiene algunas características relacionadas con el metabolismo de algunos micronutrientes.
Lactobacillus casei 431®: Puede modificar la acidez intestinal, antagonizando patógenos a través de la producción de compuestos antimicrobianos. Es un microorganismo muy eficiente para regular el sistema inmune.


En los últimos años, el uso de microorganismos para el bienestar se ha extendido a diversas aplicaciones. Entre los temas que han tenido más interés, se encuentran los relacionados con el sistema inmunológico, el sistema digestivo y el control de peso.
Investigaciones recientes señalan que a partir de probióticos adaptados en alimentos y aplicaciones nutracéuticas, es posible producir sensación de saciedad en los consumidores. El exceso de peso es una de las preocupaciones más extendida según los especialistas de la salud pública, por lo que el uso de probióticos específicos podría conducir a una interesante solución para esta problemática.
Entre las áreas de aplicación de los probióticos se encuentran: infecciones urinarias, la disminución y prevención de las enfermedades alérgicas, al igual que la prevención de cáncer de colon, entre otras. A pesar de que ha habido resultados positivos sobre el uso de probióticos como elementos terapéuticos, es necesario continuar con la investigación que permita determinar dosis óptimas, tipos de microorganismos, alimento más adecuado, etc.
Para que esta labor se traduzca hacia el futuro en beneficios tangibles para el consumidor, es necesaria la colaboración estrecha entre los fabricantes de probióticos y los fabricantes de los alimentos que los contienen.

Cada año la industria de los alimentos avanza debido al descubrimiento de nuevas necesidades entre los consumidores y el sector lácteo es reconocido por el ser el segundo en generación de nuevos productos, después de aguas y bebidas.
Los siguientes son algunos de los aspectos en los cuales habrá de evolucionar el sector lácteo con el fin de satisfacer gran parte de los intereses de los compradores del mundo:
1. Tendencia saludable
Es la más representativa de este sector y se está enfocando de diferentes maneras:
Disminuyendo o eliminando restrictores de consumo: libre/bajo/ reducido en lactosa, grasa, azúcar y colesterol.
Enfatizando en naturalidad: libre de aditivos/conservantes; se resalta el uso de sabores y colores naturales, y de fruta; surge el concepto de los “superfruits” que son alimentos elaborados con frutas que tienen un alto contenido de antioxidantes.
Creando conceptos específicos de bienestar y salud (lácteos funcionales): son desarrollos de productos que incluyen los dos ítems anteriores con la adición de otros componentes, con el fin de generar productos orientados a beneficios de salud específicos; los conceptos que están tomando mayor fuerza son:
- Salud digestiva: es la de mayor número de lanzamientos, se refiere a productos con probióticos y prebióticos y a la inclusión de cultivos especiales (en algunos casos patentados) que tienen beneficios comprobados con estudios realizados específicamente con el producto que los contiene (claims comprobados); sin embargo, en Estados Unidos se ha encontrado que el consumidor presenta confusión con respecto al significado de estos conceptos.
- Salud cardiovascular: asociada a productos bajos en grasa y colesterol y con la inclusión de omega 3.
- Crecimiento y desarrollo: mediante la fortificación con vitaminas y minerales; siendo el de mayor uso el calcio, para este caso particular, se resaltan los productos donde es utilizado milk calmium que se refiere a calcio natural obtenido de la leche.

- Control de peso: asociados a la reducción de grasas y calorías y a la inclusión de componentes que actúan como “quemadores de grasa”.
- Otras tendencias asociadas a salud: Combinaciones de lácteos con soya y análogos lácteos con 100% soya; en el primer caso, se busca combinar los beneficios de ambas proteínas y ha generado gran aceptación por el buen reconocimiento que el consumidor tiene de
Por: Luz Stella Vanegas Pérez Gerente Técnica TECNAS S.A.
la soya; en el segundo caso, son productos que se orientan principalmente a vegetarianos y a personas intolerantes a la lactosa, también están siendo muy utilizados para niños.
- Lácteos orgánicos: tendencia que continúa en crecimiento en especial en Europa.
2. Productos para grupos poblacionales específicos
Lácteos para niños: son los de mayor crecimiento, los cuales tienen una combinación de dos componentes de mercadeo: aquellos elementos que llaman la atención de los niños como las imágenes, las promociones y los juegos y aquellos de interés para los padres: formulación con beneficios para la salud orientada específicamente a este grupo poblacional, donde son más usados los conceptos crecimiento y desarrollo y desarrollo cerebral.
Lácteos para mujeres: asociados a conceptos de belleza y control de peso.
Lácteos para hombres: tendencia menos fuerte, tiene mayor numero de lanzamientos a nivel de postres congelados.
3. Tendencia de saborización
Los sabores frutales siguen siendo los más importantes en el sector lácteo, el sabor a fresa continúa siendo el de mayor importancia a nivel de bebidas fermentadas. En el caso de leches saborizadas el sabor chocolate es el más destacado; además, comienzan a generarse productos de combinaciones de sabores frutales con sabores especiados y florales. Los tradicionales chocolate y vainilla continúan siendo los sabores favoritos a nivel de helados, en esta categoría también se están incluyendo las combinaciones antes mencionadas. A nivel de quesos, el sabor plano sigue siendo el de mayor importancia, pero se han generado una serie de combinaciones que comienzan a tener gran aceptación entre consumidores, en especial se tiene el uso de especias, notas ahumadas y picantes.
4. Tendencia productos convenientes

Asociada a productos de fácil uso y que puedan ser consumidos durante el día (fuera del hogar); a nivel de quesos se tienen los productos porcionados y en presentación tipo snacks, también se incluyen dentro de esta categoría postres que no requieren refrigeración.
5. Tendencia productos económicos
Tendencia asociada a la situación económica mundial, a nivel de lácteos se han generado productos en porciones más pequeñas de las convencionales y con propuestas multipaquetes de diversos tamaños, con el fin de favorecer su adquisición a todo tipo de estratos socioeconómicos.
A nivel de lácteos se han generado productos en porciones más pequeñas y con propuestas multipaquetes de diversos tamaños, con el fin de favorecer su adquisición a todo tipo de estratos socioeconómicos.Fuente: Mintel GNPD.


El Cashrut conocido por la pronunciación como kósher, es un concepto hebreo que en español quiere decir correcto o apropiado, es el concepto que según los preceptos de la religión judía determina la condición ideal de consumo de algunos alimentos según las indicaciones bíblicas del Levítico 11.

El sello Kósher indica la pureza con la que fueron concebidos ciertos alimentos y determina si tales productos son puros o no son aptos para el consumo humano. Aunque las leyes de Kashrut no fueron creadas por razones de salud física tienen una gran influencia en el desempeño del metabolismo. Lo que es bueno para el alma es bueno para el cuerpo también.
Mercado nacional
Según el directorio judío mundial Kósher Delight el 90% de los cereales que se consumen actualmente en el mundo, tienen sello de Kósher o están revisados. El concepto y la certificación están tomando fuerza y reconocimiento en el mercado nacional y hoy en día en Colombia, es posible identificar en los supermercados productos con el estándar de pureza que Kósher reconoce.
Existen 303 compañías que certifican Kósher alrededor de mundo de acuerdo con la clasificación que se maneja. Si los sellos vienen solos y el producto se considera Parve, es decir Neutral, puede servirse con productos Lácteos o de Carne.
Cuando el sello viene acompañado de una D a un lado, el producto es Lácteo. Muchos productos especiales para Pesaj que es la festividad judía que conmemora la salida del pueblo judío de Egipto, suelen venderse durante todo el año y se reconocen por una P que traen al lado del Símbolo.
Cuando los consumidores prefieren los alimentos certificados con el sello saben que la preparación de las comidas procesadas tiene una revisión confiable, que los productos de origen animal fueron obtenidos de forma ética y naturaleza mas refinada y además de consumir un producto de alta calidad para la salud física, se está aportando a la construcción espiritual.
Existen 303 compañías que certifican Kósher alrededor de mundo.
bioMérieux ha lanzado BCI-Net para conectar sus plataformas VIDAS y TEMPO al Sistema de Manejo de Información de Laboratorio (Laboratory Information Management System, LIMS).
BCI-net es una interfaz de comunicación diseñada para simplificar y hacer más rápido y seguro el manejo de datos para análisis de patógenos e indicadores de calidad.
TEMPO automatiza las pruebas para microorganismos indicadores de calidad, incluyendo total de células viables, conteo de coliformes, E. coli, S. aureus, enterobacterias y mohos y levaduras.
La tecnología que hay detrás de este sistema se basa en un método microbiológico bien establecido llamado NMP (Número Más Probable).
Este sistema toma el método clásico de NMP y automatiza y miniaturiza el procesamiento de muestras a través del uso de pequeñas tarjetas plásticas, viales que contienen los medios y un sistema especial de análisis.
El líder mundial en sistemas automatizados para detección de patógenos en alimentos – VIDAS y su modelo compacto miniVIDAS- es un instrumento multiparamétrico que utiliza la tecnología ELFA (Enzyme Linked Fluorescent Assay) y se basa en un concepto de muestra lista para analizar.
Muchos laboratorios están invirtiendo en LIMS con el fin de cumplir con la legislación en cuanto a trazabilidad (ISO 17025) y de mejorar su productividad. BCI-net asegura una trazabilidad completa. La calidad e integridad de los datos son mejoradas ya que los análisis y resultados son automáticamente transferidos entre LIMS y las plataformas de VIDAS y TEMPO; de esta forma se reducen posibles errores de transcripción.



Conectando los sistemas de análisis de bioMérieux al LIMS, se simplifica el flujo de trabajo del laboratorio, reduciendo la transferencia manual de datos.
Estas conexiones también permiten a los clientes facilitar y acelerar el manejo de sus cadenas de suministro mediante la comprobación de los resultados de patógenos e indicadores de calidad a medida que se van obteniendo.

En conclusión, el uso de equipos automatizados en el laboratorio sumados a un manejo experto de la información le brindan herramientas de gestión con las que...

ofrece soluciones completas
¿Necesita sus indicadores microbiológicos mejor controlados?Primera solución automatizada para recuento de indicadores de calidad
...usted se sentirá completamente bajo control y además asegurará sus decisiones para las demás áreas de su compañia.
Cuando se habla de inocuidad no solo se habla del estado ideal de los alimentos en el momento de verdad con el consumidor, en realidad el término hace referencia a todos aquellos detalles que garantizan la aceptación definitiva e idónea de un producto, por parte del público para el cual ha sido diseñado.
La inocuidad es uno de los elementos que junto con las características nutricionales, las organolépticas, y las comerciales componen la calidad de los alimentos. Los pormenores de los procesos de transformación, desde la obtención de la materia prima para su realización, hasta la exposición en anaqueles o vitrinas, juegan un papel fundamental.
En el desarrollo de los procesos alimenticios, existen diversos agentes que
influyen en la calidad e inocuidad de los productos para consumo humano. No solo es importante la limpieza de los operarios y de las personas que ingresan a las plantas, también es importante mantener los equipos limpios y lubricarlos con aceites y grasas grado alimenticio H1. Los riesgos existentes por contaminación son latentes a la hora en que el alimento tenga algún tipo de contacto con una pieza lubricada, pues desmejora la calidad del producto y pone en algunos casos en peligro la salud del consumidor final.
Contaminación por lubricantes. Existen varias formas de contaminación en los alimentos, ya sea en su sabor o en su olor. Muchos ingenieros,

técnicos mecánicos o lubricadores piensan que la contaminación se da solo por contacto directo del lubricante con el producto en proceso o terminado, lo cual es un grave error, porque existe un enemigo de la inocuidad que no podemos ver: debido a que todos los lubricantes emanan vapores, siempre existe el riesgo de que estos intervengan en la calidad de la manufactura.
Han existido casos donde llegan comestibles al mercado con sapidez o aroma diferente, hablamos de marcas importantes y reconocidas en nuestro país. En Colombia, el Instituto Nacional de Vigilancia de Medicamentos y Alimentos (INVIMA), ha desarrollado algunas brigadas que de alguna manera
Existe un enemigo de la inocuidad que no podemos ver: debido a que todos los lubricantes emanan vapores, siempre existe el riesgo de que estos intervengan en la calidad de la manufactura.
han controlado el uso indebido de algunas clases de lubricantes en industrias de alimentos, pero la verdad es un trabajo que apenas comienza, y algunas compañías no acatan las recomendaciones que esta entidad sugiere.
Las normas de calidad están sujetas al cuidado de cada una de las personas que intervienen paso a paso en la elaboración de un producto alimenticio y en muchas compañías, hoy por hoy, no existe una capacitación apropiada que permita difundir dicha información dentro de la organización.

Control
La NSF (Fundación Nacional de Saneamiento) en los Estados Unidos, ha desarrollado un programa autorizado por la USDA (Departamento de Agricultura de los estados Unidos) que se rige por el Título 21 del Código de la FDA (Administración de Drogas y Alimentos) de Reglamentos Federales.
El proceso de la evaluación NSF:
1. Revisión toxicológica de los ingredientes.

2. Revisión de etiqueta.
3. Determinación de clasificación de uso.
4. Decisión de la aprobación del registro.
Se trata del registro NSF, un procedimiento formal que examina los complementos de lubricantes y certifica que están en cumplimiento con el Título 21 de la FDA. Una vez registrados los productos, el fabricante del lubricante puede usar el logo de la NSF en promoción y publicidad. Fabricantes o comercializadores cuentan con el respaldo mediante una carta de autorización que garantiza que sus productos son aptos para los usos relacionados con alimentos.
Resultado final: lubricantes con garantía de inocuidad alimentaria.
Como la NSF, también está Kosher de la comunidad Judía, Halal de la comunidad Musulmana, que autoriza el uso de este tipo de lubricantes para que sean manipulados al lado de productos alimenticios.
Las precauciones son cuestión de competitividad
Es importante garantizar que los lubricantes usados en planta no representan una amenaza para la competitividad de la compañía, no está de más verificar que sean aptos para ser usados en plantas alimenticias y comprobar que no tienen influencia alguna durante el proceso de producción.
No está demás buscar una asesoría profesional de un proveedor con vasto conocimiento en el tema de lubricantes tipo H1, los proveedores son también aliados del crecimiento de las compañías.
Si bien los productos gourmet están diseñados para un selecto grupo de consumidores y han sido característicos de países desarrollados, destacados por el arte culinario, los especialistas advierten que cada día son más los comensales colombianos que se inclinan por elegir productos que les proporcionen además de placer a su paladar, una mejor salud y mayor comodidad a la hora de consumirlos.
“La demanda se ve cada vez más favorecida en el país debido a que la gente quiere comida más sana, se preocupa por su salud, la estética y la facilidad a la hora de encontrar y consumir un producto”, dice, Daniel Rodríguez, economista y especialista en industria de alimentos.
Y aunque el precio de los alimentos gourmet es mayor en comparación con los alimentos habituales, alrededor de 5% según el producto, los consumidores de este tipo de alimentos están dispuestos a pagar un precio más elevado, siempre y cuando satisfaga su necesidad de calidad, buen gusto, originalidad y novedad.
“Los productos gourmet están encaminados hacia consumidores de alto
poder; personas que buscan refinamiento y delicadeza en los placeres de la mesa. Sin embargo es asombroso ver como, cada vez son más, los sitios que ofrecen este tipo de alimentos. Esto quiere decir que las personas sí están eligiendo ese tipo de productos, así sean unos cuantos dentro de su canasta familiar”, añade Rodríguez. Si anteriormente eran pocos los lugares, ubicados en sitios exclusivos de las ciudades, donde se podían encontrar este tipo de alimentos como enlatados, mariscos españoles; vinos argentinos, chilenos y franceses; quesos gruyer, brie, holandeses y chocolates de diferente procedencia, hoy por hoy, es frecuente encontrar, en la mayoría de supermercados, una góndola destinada para exhibir esta clase de alimentos con impulsadores que dan a conocer el producto a los consumidores no solo importados, sino de fabricación colombiana.
Caracterización del mercado colombiano
Son diferentes productos gourmet que se importan de países suramericanos, especialmente de las naciones ubicadas en el Cono Sur: Chile, Argentina y Uruguay traen al país un importante número de alimentos gourmet.
No obstante, en el mercado se encuentran también quesos y chocolates holandeses, vinos franceses; enlatados y enfrascados españoles, tés y galletas inglesas, entre otros.

La gran variedad de chocolates y tés importados, las carnes en conserva de jabalí, ciervo y trucha tienen grandes posibilidades de incursión en el país. Así lo reporta un reciente estudio argentino de mercado gourmet colombiano.
En Colombia existen grandes cadenas de distribución con mucho poder de negociación, una nueva
La Influencia extranjera en los hábitos de consumo, los viajes al extranjero la, aparición de restaurantes internacionales y la consulta de Internet son algunos de los factores que hacen que la demanda de estos alimentos gourmet haya aumentado en años recientes.Fotografía: Cortesía Rausch
tendencia de compra directa que acorta canales y otros distribuidores como supermercados, tiendas de barrio y delicatesen.
En cuanto al costo de los productos, este varía de acuerdo con el tipo de alimento y los valores de aduana y aranceles, al momento de la importación. Sin embargo, se observa una variedad de alimentos gourmet que van desde chocolates de US$2,8 hasta salmones de US$ 17, 58.
Otros productos que se encuentran frecuentemente en los almacenes gourmet del país son los tradicionales tés ingleses que se encuentran desde: US$ 0,95 a US$ 2,74, y anchoas y mariscos enlatados que van desde US$4,62 a US$ 6,58.
El sector de los productos gourmet comúnmente conocido en la industria como productos especiales “specialtyfoods” es un sector con una definición abierta, es decir es una clase de alimento o bebida que construye su valor en función de la diferenciación y la segmentación del mercado.
Igualmente, como se trata de alimentos exclusivos, carecen de producción masiva, con una escala reducida y por lo general, cuenta con un proceso productivo artesanal, tratamiento especializado que se caracteriza por su calidad y buenas prácticas, aplicadas a todo el proceso.

Los expertos explican que este mercado es un sector en crecimiento debido a diferentes factores como la globalización, las migraciones internacionales, el creciente apoyo a la micro, pequeña y mediana empresa, el aumento del ingreso de algunos consumidores que eligen este tipo de productos, y al cambio en el perfil de los comensales.
De ese modo, los importadores de este tipo de alimentos han visto en el mercado gourmet una alternativa que va en crecimiento y que si bien, aún no está en niveles de países desarrollados va por un camino alentador en este sentido.
La oferta
“Hoy por hoy, existe una buena oferta que responde a las necesidades del consumidor que demanda este estilo de comestibles. Y aunque Colombia no ocupa los primeros lugares de importación en este contexto, se puede decir que el crecimiento de este mercado se ha incrementado de manera significativa en los últimos cinco años con productos nacionales también. Este fenómeno se debe no solo a los gustos cambiantes del consumidor, sino a los acuerdos arancelarios y facilidades de importación con otros países” cuenta Carolina Moreno, profesional en Finanzas y Comercio Exterior.
Por su parte, en Colombia también se fabrican productos gourmet, aunque a menor escala y con más bajos niveles de consumo y exportación. El alimento más común en este rango es el café gourmet que se encuentra bajo las exigencias de los consumidores internacionales y algunos colombianos y turistas, radicados en el país.
De ese modo, las empresas productoras de café de exportación como Juan Valdés, Oma, Nescafé, Café Luker, Agrotropical y Café Madrid S.A, entre otros sacan al mercado nacional e intencional café gourmet en grano y molido en ofertas limitadas.
En años recientes, algunas de estas empresas han sacado al mercado nacional e internacional café tostado gourmet con el que se han conquistado nuevos mercados en el país propiamente, ya que para el año 2006 registraba, un 1% de la participación total en el mercado de café.
Los productos gourmet están encaminados hacia consumidores de alto poder; personas que buscan refinamiento y delicadeza en los placeres de la mesa.

La influencia extranjera en los hábitos de consumo, la presencia creciente de inmigrantes de diferentes regiones y el éxito de las cocinas a nivel mundial, hoy por hoy, nos permite hablar de la globalización del sabor.
Eltérmino gourmet es un vocablo francés que se refiere a una persona con gusto delicado y exquisito paladar, conocedor de los platos de cocina significativamente refinados, que tiene la capacidad de ser catador de talentos de gastronomía al probar el nivel de sabor, fineza y calidad de ciertos alimentos y vinos. Para la Real Academia Española (RAE), es sinónimo de gastrónomo: persona entendida en gastronomía, o persona aficionada a las comidas exquisitas; los productos gourmet corresponden a preparaciones especiales dirigidas a esta clase de consumidor.

Los platos tradicionales de cada región o país del mundo, han sido históricamente el resultado de mezclas y preparaciones de alimentos con los recursos y medios disponibles en momentos de crisis, asociados a guerras o cambios climáticos; sin embargo, con el tiempo, se han convertido en parte implícita de cada cultura y se han ido perfeccionando. Algunos de ellos han logrado tener tal grado de refinamiento, que han sido clasificados por los expertos como productos gourmet tales como un caviar Beluga, un prosciutto de Parma, un aceto balsámico de Módena, entre otros.
La tendencia creciente de consumo de comida internacional y de fusión ha originado una gran demanda de productos gourmet típicos de cada cultura y región. Entre las cocinas más destacadas están: la mediterránea, la mexicana que ha sufrido diferentes mezclas y combinaciones, la oriental, la china, la sofisticada cocina japonesa, la exótica cocina tailandesa y la cocina peruana tan en boga actualmente. Todas estas cocinas tienen carácter gourmet y sus elementos principales los encontramos en casi todos los supermercados del mundo, en forma de productos típicos o como productos procesados; entonces podemos decir, que la globalización del paladar y en consecuencia el mercado interno y externo, están a la búsqueda de productos con características definidas que van desde las diferenciaciones de sabor hasta la forma de empaque y practicidad.
Ingredientes, un mundo de posibilidades Contrario a lo que muchos piensan, la elaboración de esta clase de platos y su industrialización no es tan complicada como parece; para ello, la industria de alimentos tiene a su alcance un mundo de posibilidades de ingredientes con los que puede obtener los más exquisitos productos y lo más importante, estandarizar el sabor de los mismos, entre ellos se encuentran:
La tendencia creciente de consumo de comida internacional y de fusión ha originado una gran demanda de productos gourmet típicos de cada cultura y región.
Especias naturales: realzan el sabor de los alimentos y aportan aroma y color a la comida; para facilidad de almacenamiento, manipulación y garantía de un perfil de sabor siempre igual, son utilizados los extractos de especias (oleorresinas y aceites esenciales), además, las especias deshidratadas o liofilizadas cuya presentación puede ser en polvo o en trozos; en todos los casos, corresponden a propuestas que conservan las características sensoriales requeridas según el tipo de preparación.
Saborizantes específicos: pueden ser de origen natural o artificial, proponen notas de sabor requeridas para dar un perfil específico a diversas clases de alimentos, pueden ser frutales (muy utilizados ingredientes de origen natural como frutas deshidratas en trozos o en polvo y aceites esenciales como limón, naranja, mandarina), dulces (como vainilla, chocolate; además, uso de productos naturales en polvo como arequipe, miel, crema de leche), lácteos, alicorados (notas tipo vino, brandy, ron o anisadas ), salados (cárnicos, vegetales), tipo parrilla (obtenidos a partir de humos condensados a los cuales se les han retirado los componentes que pueden causar riesgo a la salud, dan perfiles ahumados, de parrilla y notas rostizadas), también son muy usados los perfiles tipo madurados para productos cárnicos y quesos.
Potenciadores o redondeadores de sabor: tienen mayor aplicación los de origen natural, obtenidos a partir de extractos de levadura, con los cuales se obtienen bases de perfiles específicos como carne de res, cerdo o pollo; además, pueden ayudar a redondear notas vegetales.
Colorantes: son requeridos para realzar el color de las comidas; es por ello que deben ser de preferencia de origen natural (a partir de achiote, zanahoria, cúrcuma, remolacha, espinaca, tomate, entre otros); se encuentran disponibles en diversas concentraciones y se han
generado mezclas de ellos para obtener la tonalidad y estabilidad requeridas según la clase de preparación alimenticia.

En los alimentos industrializados es común el uso de agentes doradores; ya que muchos de ellos se desarrollan como platos listos para calentamiento en microondas, donde el uso de ingredientes convencionales no permitirá la formación de color dorado propio de ciertos alimentos.
Agentes que proporcionan textura: son fundamentales para espesar, estabilizar, dar cuerpo o rigidez según el plato deseado; es importante considerar que los consumidores prefieren los productos crocantes por fuera y cremosos y blandos por dentro; esta clase de ingredientes son usados en las preparaciones de glaseados, salsas, sopas, helados, productos de panadería y repostería, entre otros.
Sistemas de cobertura: usualmente utilizados para imitar la preparación casera de uso de huevo fresco y empanizados; a nivel industrial, se utilizan bases como batidos (batter) que proporcionan las características de adherencia, espesor y sabor requeridos, unidos a propuestas de migas de pan y cubiertas (breader) que proporcionan crocancia, color y dan un aspecto muy agradable a los alimentos.
Opciones funcionales para productos exquisitos
Además de los ingredientes en forma independiente; la industria cuenta con la posibilidad de preparaciones básicas que corresponden a mezclas que pueden facilitar los procesos de uso a nivel de HORECA (Hoteles, Restaurantes y Casinos) y a nivel de industrialización, estas corresponden a bases listas para hacer sopas, arroces, postres, salsas, entre otros; además, mezclas de especias y saborizantes correspondientes a los sabores propios de una preparación o plato regional.
Como se puede observar en la descripción de los ingredientes, se resalta mucho el uso de productos de origen natural; ello va acorde con una de las principales tendencias en alimentos
La industria de alimentos tiene a su alcance un mundo de posibilidades en ingredientes con los que puede obtener productos gourmet de calidad y lo más importante, estandarizar el sabor de los mismos.
como es la saludable, en este campo, las preparaciones gourmet están orientadas a dos enfoques principales:

1. Resaltar la naturalidad de sus materias primas y la simplicidad de los procesos de preparación.

2. Disminuir o eliminar algunos componentes para poder declarar beneficios de salud como: bajo en grasa, libre de colesterol, libre de lactosa, sin azúcar y sin gluten, principalmente.
Este escenario sitúa a la industria alimentaria frente al reto de investigar y desarrollar productos gourmet accesibles a un grupo objetivo cada vez más amplio, que muestra creciente preferencia por productos gourmet para paladares
exquisitos y por alimentos naturales, sofisticados y con énfasis en la calidad. El mercado actual demanda nuevas tendencias y aplicaciones, como son “fácil de usar”, “fácil de cocinar”, como fuente de valor agregado. Al mismo tiempo, debe tener en cuenta el factor socio cultural y el carácter étnico del consumidor objetivo, pero lo más importante a un precio más accesible.
Para la producción de alimentos gourmet se debe tener en cuenta el factor socio cultural y el carácter étnico del consumidor objetivo, pero lo más importante a un precio más accesible.
 Por: Andrés Gómez Orozco Ejecutivo de Cuentas Kantar Worldpanel
Por: Andrés Gómez Orozco Ejecutivo de Cuentas Kantar Worldpanel
En los tiempos de crisis toda la industria ha tenido que incrementar sus esfuerzos para mantener sus marcas en el mercado y evitar perdidas que afecten su participación. Para esto, las compañías han implementado estrategias innovadoras y eficientes ante un consumidor cada vez más exigente, que busca la mejor calidad al mejor precio en cualquier tipo de producto.
En medio de toda la especulación y la incertidumbre que ha generado la crisis mundial, en Colombia existen hogares que están desinformados y que no saben a ciencia cierta que el país está pasando por un momento difícil donde la mayoría de los colombianos, piensa en ahorrar disminuyendo sus gastos en diversión, turismo, entre otros rubros que representan inversiones significativas.
Esta desinformación que se evidencia en los niveles bajos (estratos 2 y 3) en comparación con los niveles altos (estratos 4, 5 y 6); que se encuentran muy bien informados y que están tomando medidas para mitigar los efectos del fenómeno, presenta una gran oportunidad para las empresas en términos de innovación, dado que los hogares de los niveles bajos han cambiando sus hábitos de consumo incrementando las visitas al punto de venta y comprando formatos más pequeños que suplen sus necesidades en el corto plazo.
Los consumidores en la actualidad aprovechan promociones abasteciéndose en mayor medida e incrementando el consumo, de aquellos productos que han cambiado su forma de distribución y su empaque siendo ahora más atractivos por sus bajos precios.
La dinámica de consumo que está influenciada por los hogares de los niveles bajos, tiene un efecto directo sobre los canales de distribución, siendo este quizás, el factor más sensible de cualquier producto en el mercado.
Las amas de casa actuales son prácticas y buscan la mejor opción para realizar sus compras, por esta razón, durante el 2009 los canales preferidos fueron las tiendas tradicionales y los minimercados, siendo estos canales de conveniencia que ofrecen un buen surtido con tamaños pequeños a un precio que se ajusta al presupuesto de estas familias de niveles socioeconómicos bajos, y lo más importante, sin tener que desplazarse muy lejos de casa.
Datos clave en bebidas: Durante 2009 se incrementó el consumo de la canasta de bebidas refrescantes (gaseosas, aguas y jugos) en los hogares colombianos, respecto al 2008. Este crecimiento en volumen (26%) y valor (33%), se ha generado principalmente por las bebidas sin gas, donde los jugos y néctares son los que han incrementado su volumen en mayor medida (77%), seguidos por las aguas embotella das (29%) y las gaseosas que muestran el menor crecimiento con un 18%.
Las tiendas tradicionales y los minimercados son los canales de distribución que han generado un mayor crecimiento debido a la facilidad que les brinda a los consumidores por su cercanía y por el surtido que ofrece, con formatos/tamaños más pequeños y un menor desembolso en comparación a lo encontrado en los autoservicios o las Grandes Cadenas. Esa preferencia por el canal tradicional, representa una gran oportunidad para todas las compañías que deben innovar y optimizar su distribución para incrementar la rentabilidad.

Durante el 2009, 6.400.000 de hogares colombianos (99%) compraron bebidas refrescantes para consumirlas dentro del hogar, 304.200 más que en el 2008. Los Jugos y Néctares incrementaron la presencia en 877.200 hogares, logrando llegar a un total de 5.254.000, siendo estas las bebidas que muestran un mejor desarrollo de consumo y mejoran su participación en volumen dentro de la canasta, pasando del 10% al 15% en el mercado.

El consumo promedio de los Jugos se incrementó (47%), pasando de 16 litros durante en 2008, a 23 litros durante 2009. Este desarrollo en el consumo, se presenta debido a que los hogares están comprando cantidades más grandes, pasando de 1 a 1,2 litros, y están incrementando el número de visitas al punto de venta, de 15 a 19 visitas. Este crecimiento que se evidencia en el mercado de Jugos, se debe a la entrada de nuevos competidores que ofrecen formatos más grandes a un menor precio, siendo muy atractivos para los hogares en tiempos de crisis, disminuyendo el precio promedio del mercado en un 10%.
Los hogares que incrementaron en mayor medida el consumo de Jugos, se encuentran concentrados principalmente en la ciudad de Medellín, Región Pacífico, Región Centro, los estratos 1, 2, 4, con amas de casa jóvenes menores de 34 años, que prefieren comprar en los minimercados y las tiendas tradicionales.
Las amas de casa actuales son prácticas y buscan la mejor opción para realizar sus compras, por esta razón, durante el 2009 los canales preferidos fueron las tiendas tradicionales y los minimercados.
La entrada de Jugos de Soya en Colombia la ha hecho toda Ades desde su llegada a principios de los años 90 y ha representado todo un proceso de educación del paladar y del imaginario entorno a la soya. IAlimentos habló con Juanita Concha Gerente de la marca Ades en Unilever, acerca del trabajo de innovación que ha hecho la compañía; desde la planeación de característica especiales para el producto, hasta el entendimiento con los consumidores. Jugos Ades compite en una de las categorías más grandes del mercado en Colombia, la categoría de bebidas, y para estar a la vanguardia ha sido necesario implementar en sus procesos industriales una gran diferenciación.
A continuación se detallan todos aquellos aspectos de innovación que fueron implementados para el relanzamiento de jugos Ades a finales de 2009 e incios de 2010.

Empaque diferenciador tetra square en presentaciones de 1 litro y de 200 ml y tapa abre fácil.
Educar en la soya: Para posicionar un producto en el mercado es necesario dar a conocer a los consumidores cuales son las propiedades más sobresalientes del mismo.
- Los granos de la soya son una fuente esencial de proteína, fibra y ácidos grasos no saturados.
- Al evaluar la proteína de la soya, por el método oficial establecido por la Organización Mundial de la Salud (OMS), la FAO (Food and Agriculture Organization) y la u.S. Food and Drug Administration (FDA por sus siglas en inglés) que es el PDCAAS por sus siglas en inglés que significan Score de Aminoácidos Corregido por Digestibilidad Proteica-, resulta que tiene un perfil de aminoácidos y digestibilidad adecuados. Es decir, tiene un PDCAAS cercano a 1, que es la calificación más elevada, y es equivalente a la calificación de la proteína de la leche y del huevo.
Posicionamiento de características esenciales: no contiene conservantes y por contener soya no tiene lactosa, ni colesterol naturalmente.
Existe una tendencia que afirma que todos los alimentos deben tener menos de 100 kilocalorías por porción y Ades tiene 70 kilocalorías por porción.
Lanzamiento del nuevo sabor lulo naranjilla.
Reformulación del producto con la mezcla de Vitamina B1 que estimula la producción de energía en el organismo, Vitamina B6 para fortalecer el sistema inmunológico, Vitamina B12 contribuye en los procesos de generación de energía, incluyendo la digestión, respiración, circulación y regulación de la temperatura. Ácido fólico, esencial para la reproducción celular, Vitamina C evita enfermedades degenerativas, el Hierro participa en la producción de energía.

Excepto los casos de gaseosas como Colombiana y Manzana Postobon, los sabores de la línea de las bebidas no alcohólicas en el país son tradicionales, por tal motivo los sabores ya mencionados son líderes del segmento, autóctonos y únicos, que se posicionaron en el país y con el tiempo se han convertido en parte de la identidad de los consumidores. Colombia es un país seguidor de preferencias, no creador; en la gran mayoría, de productos de las categorías de alimentos y bebidas, las tendencias y sabores llegan de Europa y Estados Unidos; se estudian, se analizan, se depuran y se dimensionan para llevarlos aplicados en concepto al consumidor, quien finalmente los aprueba.



No solamente con la aprobación organoléptica basta, se necesita tener en cuenta durante la investigación de la introducción de nuevos sabores en el mercado, todas las variables de costos, precio al canal, al consumidor y es allí donde muchas veces mueren los proyectos. Productos y sabores que gustan, pero con precios al consumidor que estos no están dispuestos a pagar.
Un ejemplo muy claro es el caso de productos que existen en el mercado con sabores artificiales o idénticos al natural y cuando se llevan a investigación con una actualización del mismo sabor, pero acorde a la tendencia de lo saludable o natural, que cuestan y valen más, no es aceptado, el consumidor no está dispuesto a pagar más por el hecho de ser natural.
En los últimos años hemos visto el nacimiento de nuevas categorías; producto del interés del consumidor en los hábitos saludables, que generan bienestar
té; agua, néctar y leche saborizada de soya.
y que aportan funcionalidad como es el caso de las categorías: té; agua, néctar y leche saborizada de soya. En cada una de estas existen sabores típicos que generan volúmenes interesantes para las empresas.
Sabores que lideran
• En el caso del te, los sabores que sobresalen en el mercado son limón y durazno. La historia de otros países y estudios avalan que son los sabores más vendidos en el mundo en esta categoría y que fueron el inicio de los Té saborizados.
• En aguas son los cítricos la opción número uno por su condición refrescante.

• En néctares y leches saborizadas de soya son los sabores indulgentes de frutas como el durazno, la pera, la manzana.
• En bebidas energéticas son los sabores confitados perfiles frutos rojos.
Nuevas alternativas, más oportunidades
Cada categoría y tipo de producto tiene su huella de sabores y esto no se puede desconocer. Se deben realizar extensiones de sabor en la línea para ampliar portafolio, ofrecer nuevas alternativas al mercado, generar noticia con la marca y abrir nuevas oportunidades a nichos de mercado que no consumían y podrían hacerlo mediante la aplicación con otro sabor.


Se deben realizar extensiones de sabor en la línea para ampliar portafolio y ofrecer nuevas alternativas al mercado.
Esta afirmación puede parecer rara, sin embargo Hipócrates ya conocía las propiedades laxantes del salvado y, más recientemente, a partir del fin del siglo XIX, el científico Elie Metchnikoff, sugirió a través de la observación de pastores búlgaros que consumían productos de leche fermentada, que la longevidad podría ser alcanzada a través del equilibrio de la flora intestinal. En la década del 50, el médico Denis Burkitt, a través de comparaciones realizadas entre las dietas de las poblaciones de África (ricas en fibras) y Europa Occidental (basada en cereales refinados y productos animales), llegó a la conclusión de que una dieta rica en fibras y un estilo de vida saludable tienen un papel protector para innúmerables enfermedades gastrointestinales y otras enfermedades típicas de la actualidad como dislipidemías y diabetes.
Actualmente, está científicamente comprobado que con una alimentación rica en fibras, pre y probióticos, podemos vivir más y con mayor calidad de vida; como si el intestino fuera un espejo que reflejase su salud y, consecuentemente influyese también en su auto-estima.
¿Pero, cómo mantener una alimentación saludable en la agitación de la vida diaria?
Danisco no mide esfuerzos para desarrollar ingredientes para la producción de alimentos más saludables, y tenemos la solución para el aumento del tenor de fibras de su producto!
Litesse® es un carbohidrato de especialidad, de bajo valor calórico (apenas 1kcal/g) y bajo índice glicémico (4-7), que presenta propiedades prebióticas y es ampliamente reconocido como fibra alimentaria en América Latina y en el resto del mundo.

En uno de los estudios clínicos realizados, donde se estudiaron los efectos fisiológicos de la ingestión diaria de diferentes cantidades de polidextrosa, comparados con un grupo control, se observó que, inclusive con dosis tan pequeña como 4g/día ya se observa:
Mejora en las funciones intestinales
Reducción de la absorción de glucosa en el intestino delgado Producción de ácidos grasos de cadena corta, principalmente de butirato (importante protector de la mucosa del colon)
Disminución del pH intestinal y aumento de la población de Bifidobactéria y Lactobacillus (bacterias benéficas) en el intestino.


de ir a las secciones de alimentos de los supermercados en cada una de las ciudades que visitamos, y de buscar información sobre lanzamientos de alimentos funcionales en el mercado, hemos notado que los productos que promueven la salud digestiva de cierta manera se han vuelto genéricos, el consumidor recibe mensajes muy similares y a veces confusos sobre los beneficios de la fibra, de los prebióticos y de los probióticos. ¿Qué tiene la industria de ingredientes para sorprendernos?
Las enzimas digestivas son proteínas complejas que participan en la digestión y asimilación de los nutrientes haciendo que estos sean más aprovechables por el aparato digestivo, una alteración de las enzimas digestivas no permite que nuestro organismo reciba los nutrientes necesarios ocasionando deficiencias
nutricionales; las enzimas también ayudan al organismo en la destrucción de agentes microbianos, tienen un papel importante en la liberación de sustancias tóxicas, y en la activación de otras enzimas y hormonas . Adicionalmente, proporcionan confort digestivo evitando o disminuyendo los calambres, el exceso de gases, la intolerancia a determinados alimentos, y la inflamación, beneficios que empiezan a ser utilizados por la industria para diferenciar sus productos nutraceúticos en un escenario que tradicionalmente se ha limitado a las formulaciones con fibras, prebióticos y probióticos.
El uso de enzimas como ingredientes funcionales representa una nueva dimensión en la formulación de productos para la salud digestiva, al mismo tiempo que pueden ser utilizadas como una alternativa natural para mejorar la eficiencia en procesos productivos.
El cuerpo humano produce aproximadamente 22 tipos de enzimas y aunque más del 40% de las proteínas que genera el organismo son para la producción de enzimas propias, es preciso también abastecerse a partir de los alimentos.
Con un poco de creatividad, muchas frutas y vegetales pueden ser utilizadas para mejorar la salud digestiva debido a las enzimas que contienen, veamos a continuación algunos ejemplos:
Investigaciones han demostrado la eficacia de aceite de menta por su contenido de piperina como relajante de los músculos gastrointestinales.
La piña y la papaya, por su contenido de bromelina y papaína, respectivamente, son eficaces para reducir la inflamación del intestino.
El ají y los pimentones, por su contenido de capsaicina, protegen las membranas gástricas y estudios indican que su consumo podría impedir el desarrollo de úlceras.
El aloe vera puede aliviar enfermedades inflamatorias gastrointestinales como la colitis ulcerosa y la gastritis debido a que promueve la cicatrización de las lesiones gástricas.

• Ecobrands en Reino Unido desarrolló ActiMint, una menta natural con Lactobacillus acidophilus, sinergizando la actividad de la menta con la de los probióticos.

Las enzimas se desactivan bajo ciertas condiciones de proceso, o incluso durante la cocción y el almacenamiento de los alimentos; de hecho, en la fabricación de algunos productos la desactivación enzimática es deseable para evitar deterioro de los mismos; siendo está una razón más por la cual reconocidos nutricionistas alrededor del mundo recomiendan consumir alimentos crudos o mínimamente procesados.

Regulación sobre enzimas digestivas y su uso en alimentos.
En Europa, la utilización de enzimas en la industria alimentaria está regulada por el Reglamento 1331/2008 del Parlamento Europeo y del Consejo, de 16 de diciembre de 2008, por el que se establece un procedimiento de autorización común para los aditivos, las enzimas y los aromas alimentarios. En Estados Unidos, las enzimas para uso alimentario están regulados como aditivos alimentarios en
virtud del Título 21 del Código Federal de Reglamentos de la FDA, parte 173 y se reconocen como GRAS (Generally Recognized As Safe).
Las enfermedades del sistema digestivo en Colombia son una de las principales causas de mortalidad de la población, en efecto la tasa de es de 14 muertes por cada 100 mil habitantes; además, problemas como estreñimiento, colon irritable y acidez, entre otros, afectan cotidianamente gran parte de la población.
• La compañía estadounidense Divine desarrolló la línea de barras nutricionales Prana Bar, con el concepto de “activación enzimática” (enzime active), que desnaturaliza los inhibidores de la acción enzimática en el organismo, y se posiciona como un producto benéfico para la salud digestiva e intestinal.

• La compañía húngara Naszalytej lanzó recientemente el yogurt Alve, que contiene 10% de trozos de aloe vera, y sus claims hacen referencia a la salud digestiva y salud del intestino.

Para Lácteos Campo Real, la innovación es sinónimo de crecimiento y competitividad, por tal motivo este 2010, la empresa inició con la constitución de su área de investigación, desarrollo e innovación y espera entrar a competir en mercados internacionales con los mejores quesos tipo pera del mercado.

y comercializa quesos con altos estándares de calidad que responden a las exigencias y expectativas de los consumidores, clientes, empleados y socios, conservando el medio ambiente y con la idea de promover el desarrollo sostenible para el país. La especialidad de Lácteos Campo Real, son los quesos tipo hilados producidos de forma artesanal.
La compañía se encuentra activa en el mercado nacional desde hace 7 años, con un crecimiento prometedor y hoy en día se posiciona como la segunda marca en su categoría de queso pera y ha venido incursionando con mucho éxito en otras categorías de quesos frescos y madurados, dicho desarrollo se ha cimentado en el compromiso, la responsabilidad y la excelencia en todos los procesos. La marca Campo Real se encuentra presente en las principales Cadenas de Supermercados como Carrefour, Almacenes Éxito, Carulla, Olímpica, Cafam, Colsubsidio y La 14.

Últimos lanzamientos
- Queso relleno de arequipe.
- Queso relleno de mora.
- Cuajada fresca.
- Queso Mozarella tajado.
- Queso campesino.
- Quesos madurados naturales y con especies
Crecimiento progresivo
A pesar de los factores que restringieron el mercado. Lácteos Campo Real ha logrado obtener crecimientos importantes
La responsabilidad social es uno de los temas de mayor importancia para Campo Real, en la actualidad laboran 37 personas directamente con la compañía, en su mayoría mujeres cabeza de hogar que representan la responsabilidad y el progreso de las familias colombianas.
por encima del sector. El año pasado la compañía creció un 20%, un comportamiento muy impulsado por el dinamismo, la ampliación de su portafolio en la categoría de quesos, la apertura de nuevos canales de distribución y el desarrollo de nuevos productos.
Según Luz Marina Mora, Gerente de Lácteos Campo Real, esta compañía crece porque busca presentar propuestas diferenciadoras, tratando de generar valor a los clientes y entregando al cliente la mayor calidez en el servicio que ofrece.
El reto más importante que ha enfrentado la compañía, ha sido lograr a su escasa edad una posición privilegiada en el mercado a nivel nacional, conquistar la confianza del cliente como una marca de calidad, incursionar en un mercado tan exigente como el de Estados Unidos, con unos resultados extraordinarios y lograr conformar un equipo de trabajo comprometido con una filosofía de servicio y responsabilidad con los productos que se manejan.
Campo Real ha avanzado con el respaldo permanente de las Universidades, de sus Proveedores, de sus Clientes y el mejoramiento en los procesos de producción. La empresa cuenta desde el 2009 con certificación ISO 9001:2000 y está adelantando el proceso de HACCP para estar alineados con las exigencias del mercado nacional e internacional.
Cuando se habla de innovación en Campo Real, se hace referencia a aspectos como: el desarrollo de productos con base en las necesidades del consumidor, estar a la vanguardia de las tendencias mundiales en alimentos; especialmente en lo que se refiere a los lácteos, la optimización de los procesos, logrando mayores eficiencias que se reviertan al cliente en productos de alta calidad a precios justos.

El Premio Nacional de Quesos CNLM 2008 otorgó la medalla en la categoría de Queso Pera a Lácteos Campo Real empresa Bogotana que se ha destacado por elaborar artesanalmente el producto garantizando una textura única y así mismo ha logrado innovar con el Queso Pera relleno de diferentes frutas.

Nestlé continúa innovando, esta vez con el cereal integral con grano entero Atendiendo a las necesidades del consumidor y con el objetivo de mejorar el estilo de vida de los colombianos, Nestlé lanzó al mercado el cereal integral con grano entero. El Comité de la Sociedad Latinoamericana de Nutrición, dedicado a estudiar los beneficios de los cereales del grano entero en la salud, afirma que el consumo de cereales integrales es asociado a la disminución del riesgo de enfermedades cardiovasculares.


Luego de recorrer el territorio colombiano durante varios meses, se detectó que uno de los inconvenientes del pequeño y mediano productor de quesos, es la poca oferta de un cuajo confiable, con excelente calidad y a costo razonable. Como respuesta a esta necesidad, Chr. Hansen desarrolló en su laboratorio de Bogotá el Cuajo Líquido TITANIUM x 500 ml, para brindar al mercado colombiano un mejor producto, orientado a una amplia gama de fabricantes de queso; desde las mayores plantas hasta el pequeño productor semi-industrializado. Una botella del cuajo líquido TITANIUM x 500 ml sirve para cuajar 5.000 litros de leche.
Danisco inaugura laboratorio de microbiología en América del Sur

Utilizando modernos recursos, y siguiendo los estándares legales de calidad que el mercado exige, Danisco inauguró su laboratorio de contaje de bacterias lácticas. La instalación, situada en el Centro de Innovación de la empresa, en Cotia, región de la gran São Paulo, atenderá a toda América del Sur. En 2009, se realizaron los primeros análisis para clientes de Brasil y Chile. La novedad ampliará la gama de servicios ofrecidos a los clientes de la marca HOWARU - línea de probióticos premium de Danisco. Traerá agilidad al tiempo de respuesta de análisis microbiológicas especializadas, ya que anteriormente éstas se realizaban en Estados Unidos, o en pocos laboratorios capacitados de la región. Traerá, además, economía de recursos.
Diageo y Buchanan’s le apuestan a la responsabilidad social
La plataforma de responsabilidad social de Diageo Learning for Life continua trabajando por transformar materialmente la vida de la comunidad de Pasacaballos en Cartagena de Indias, y a la fecha ha impactado directamente a 187 personas y a 885 indirectamente. Parte de los fondos que Buchanan’s Forever recaude en su tercera edición en Colombia con el cantante Sting, se destinarán a continuar en la implementación del Proyecto Emprendedor a través de la Fundación Antonio Restrepo Barco, que ofrece a los miembros de la comunidad de Pasacaballos los conocimientos y las herramientas prácticas para ser productivos y autosostenibles en el futuro.

A efectos de mejorar la capacidad de las empresas de adaptarse rápidamente a los eventos no planificados de la cadena de abastecimiento, Oracle anunció que ya está disponible Oracle Rapid Planning. El nuevo producto de planificación de la cadena de valor promueve la toma de decisiones en tiempo real.
Harinera del Valle lanzó la nueva línea de salsas Premium
Bucatti
Las Nuevas Salsas Premium Bucatti llegan a Colombia con tres exquisitas recetas italianas, elaboradas con la mejor calidad, ingredientes frescos y naturales, ideales para aquellas personas que buscan practicidad y el mejor sabor. La calidad y versatilidad de las salsas Premium Bucatti, son ideales para acompañar recetas con pastas largas, cortas, lasañas, carnes, aves, pescados o como base para pizzas, pasabocas, entre otras muchas posibilidades más.



